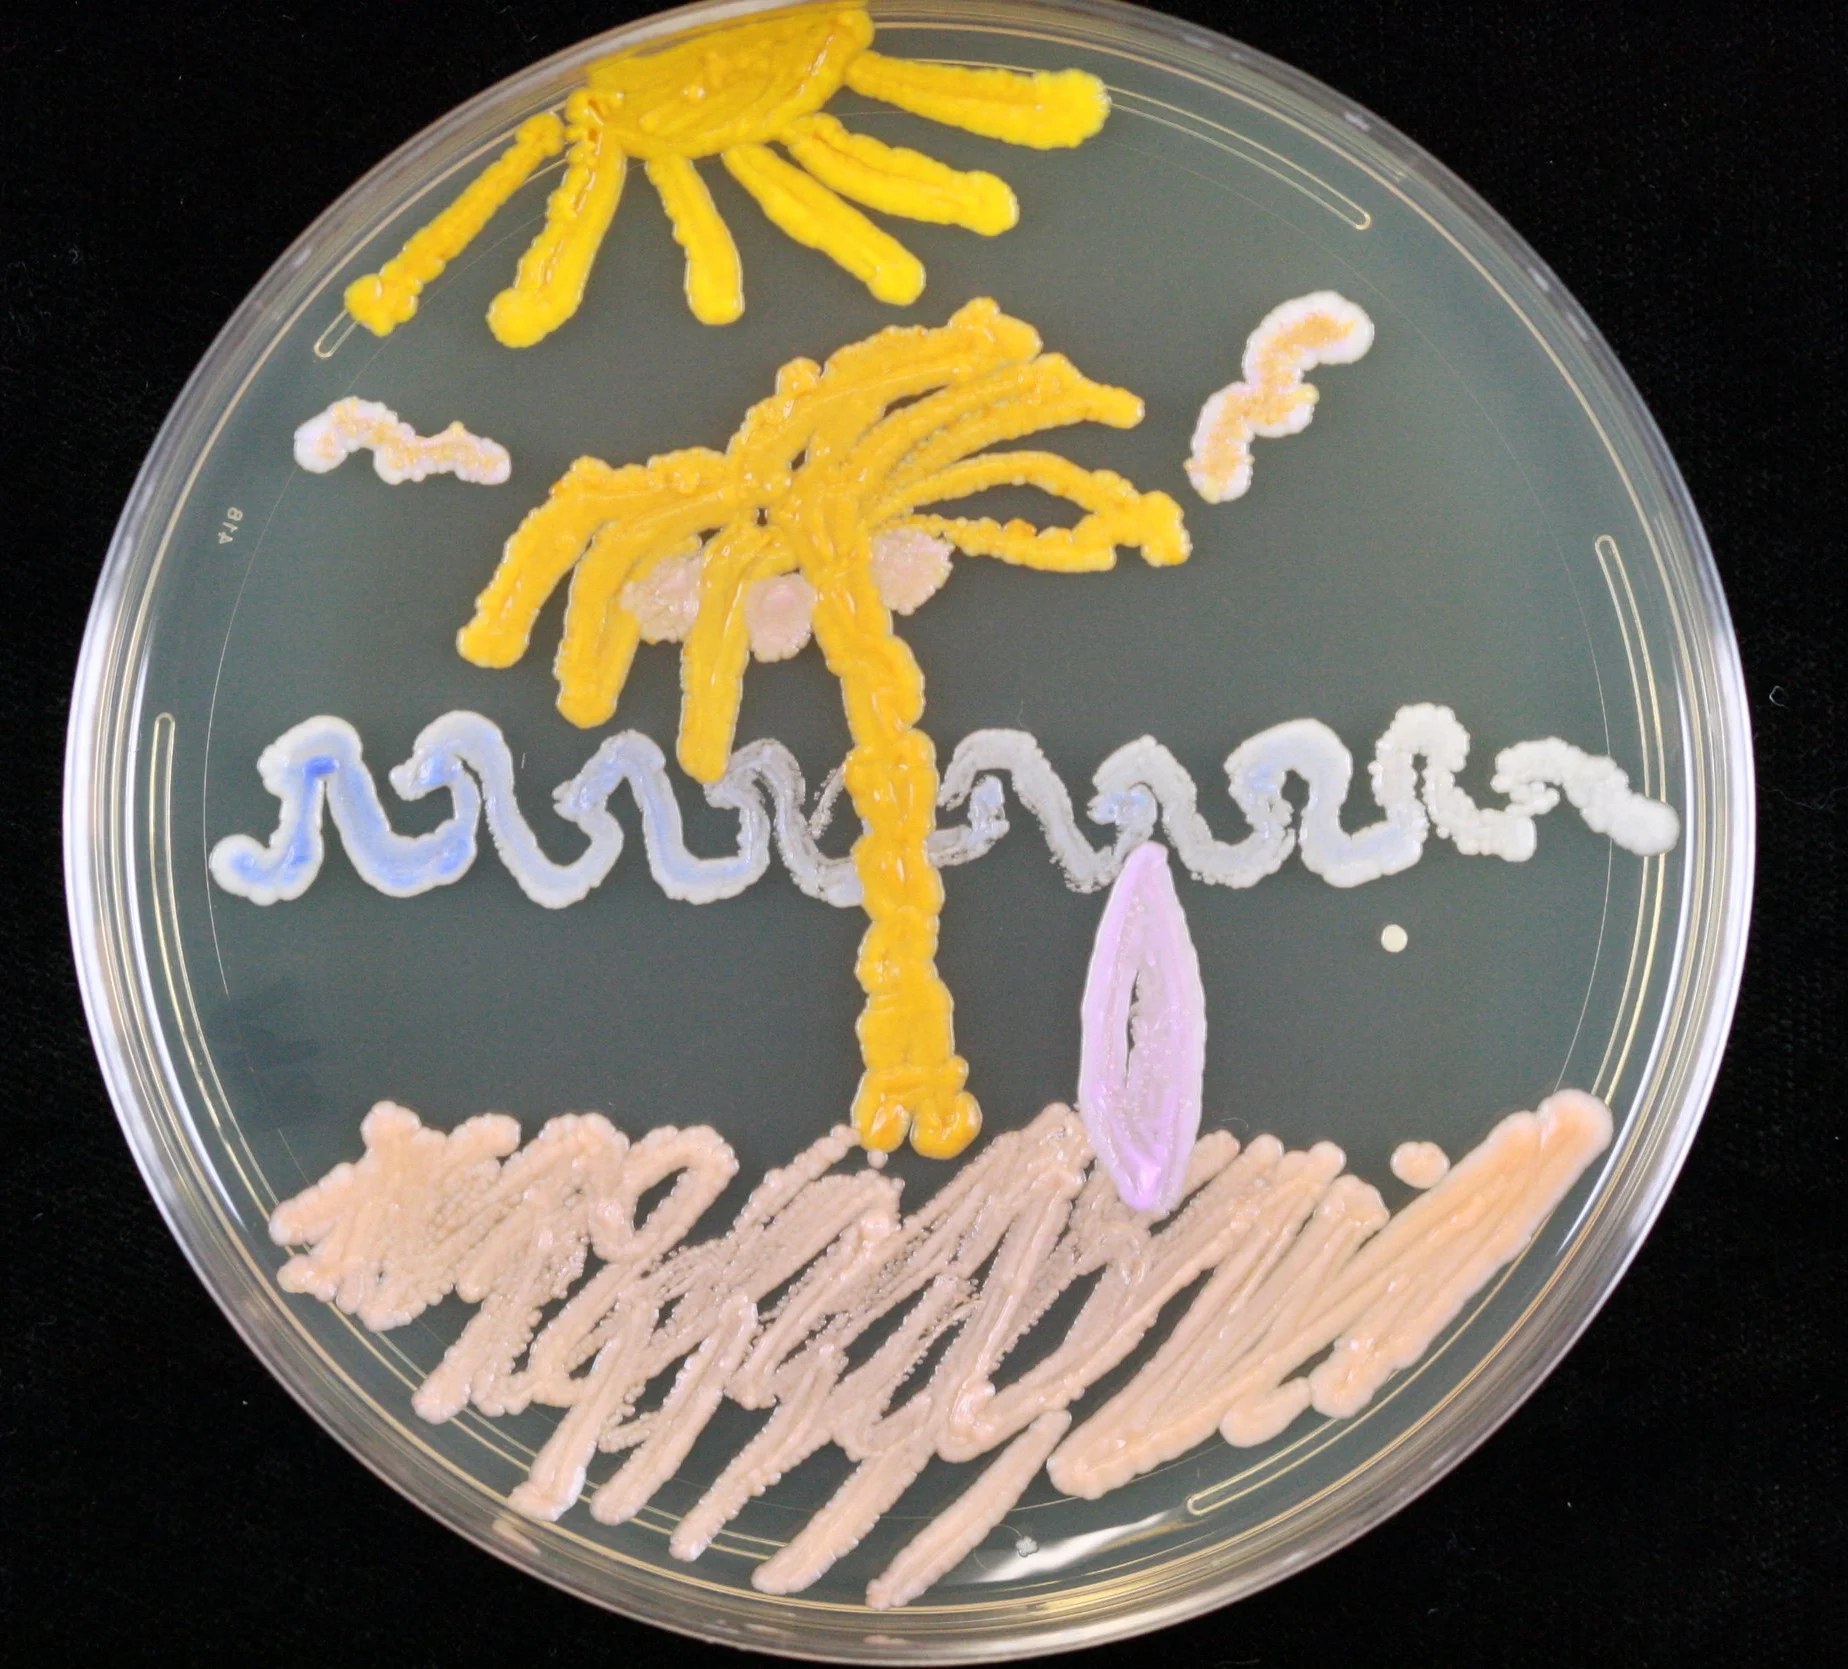
IMG_0001.JPG
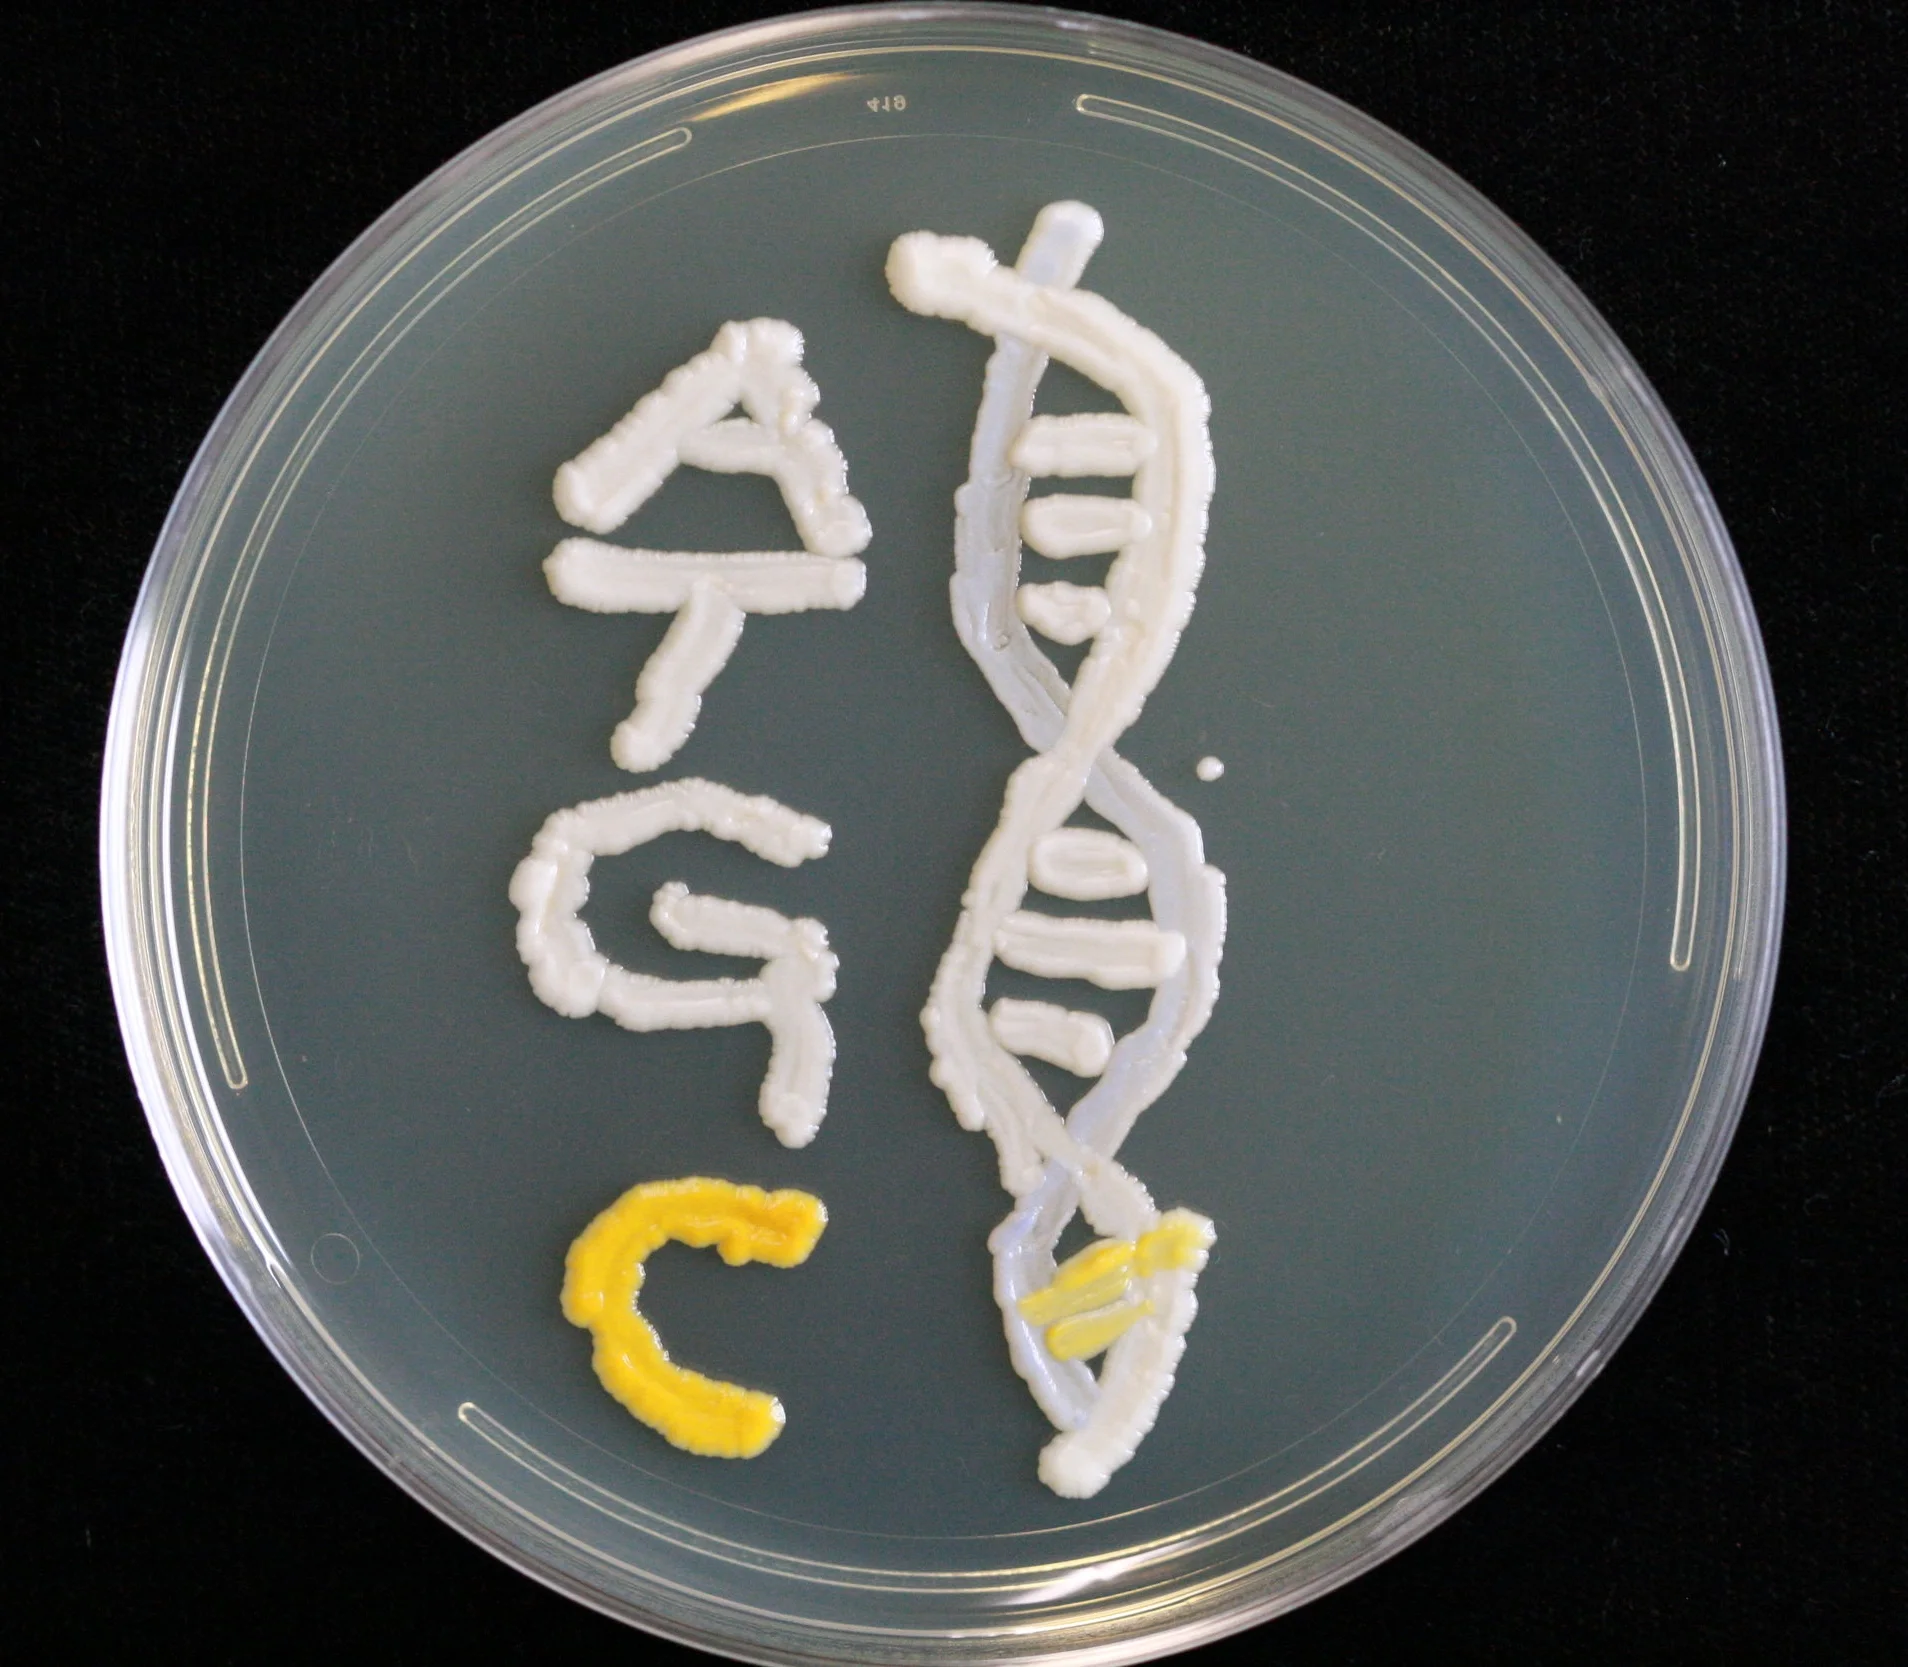
9.1.2016_3.JPG
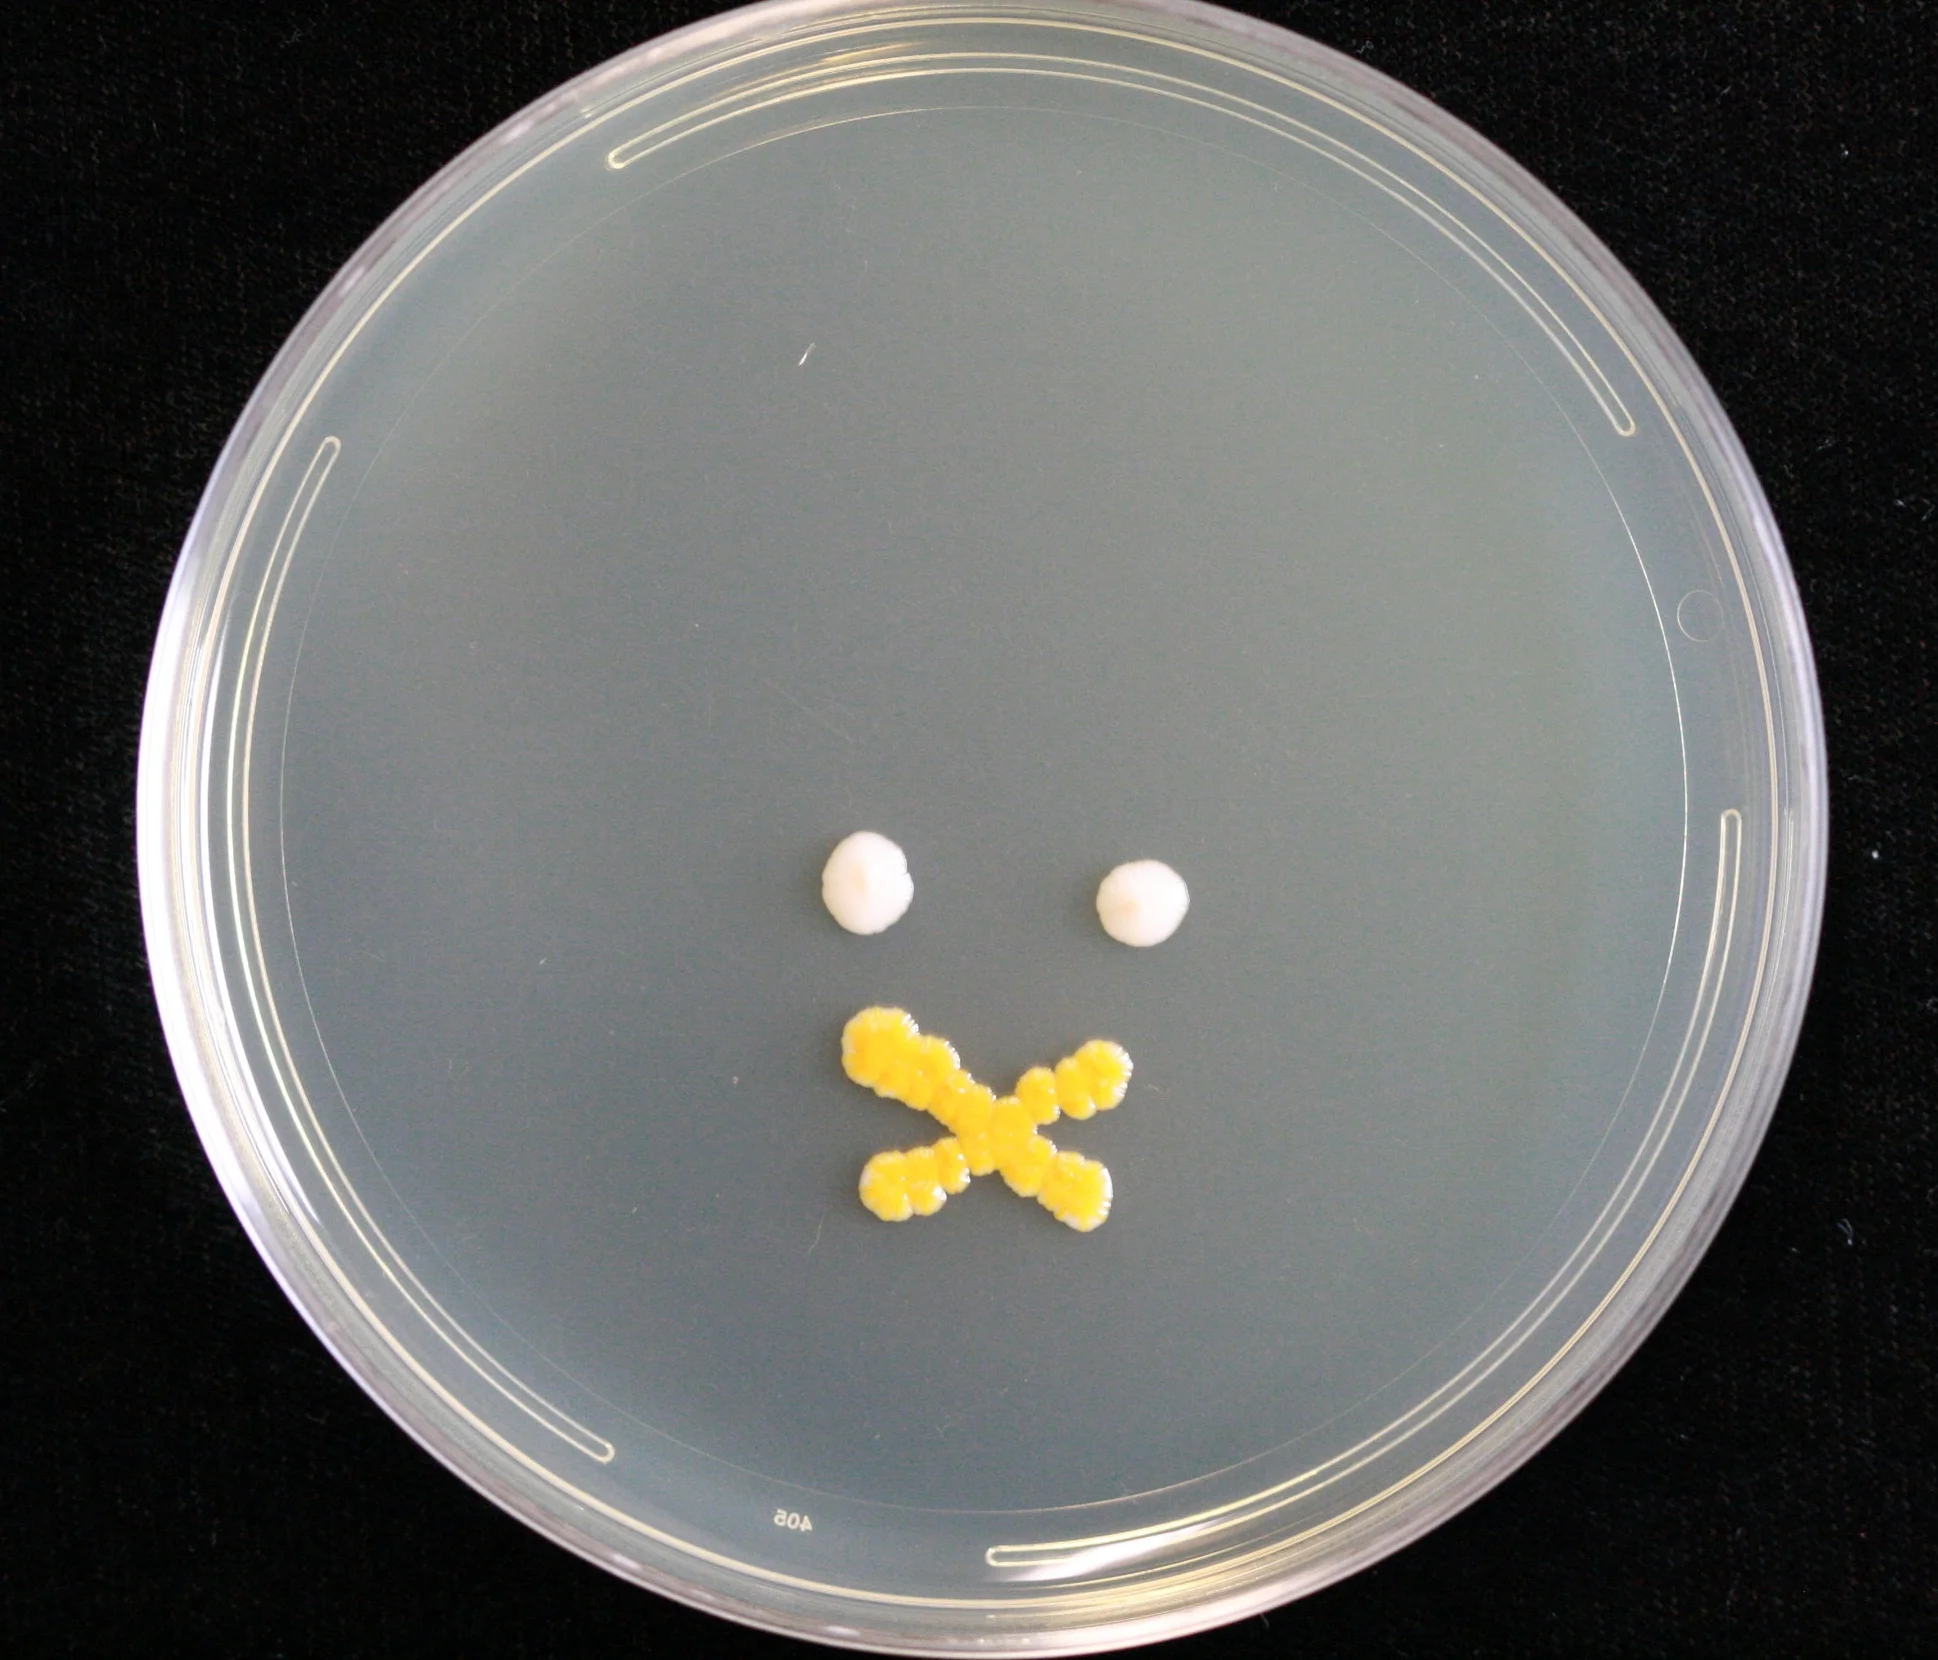
9.1.2016_5.JPG
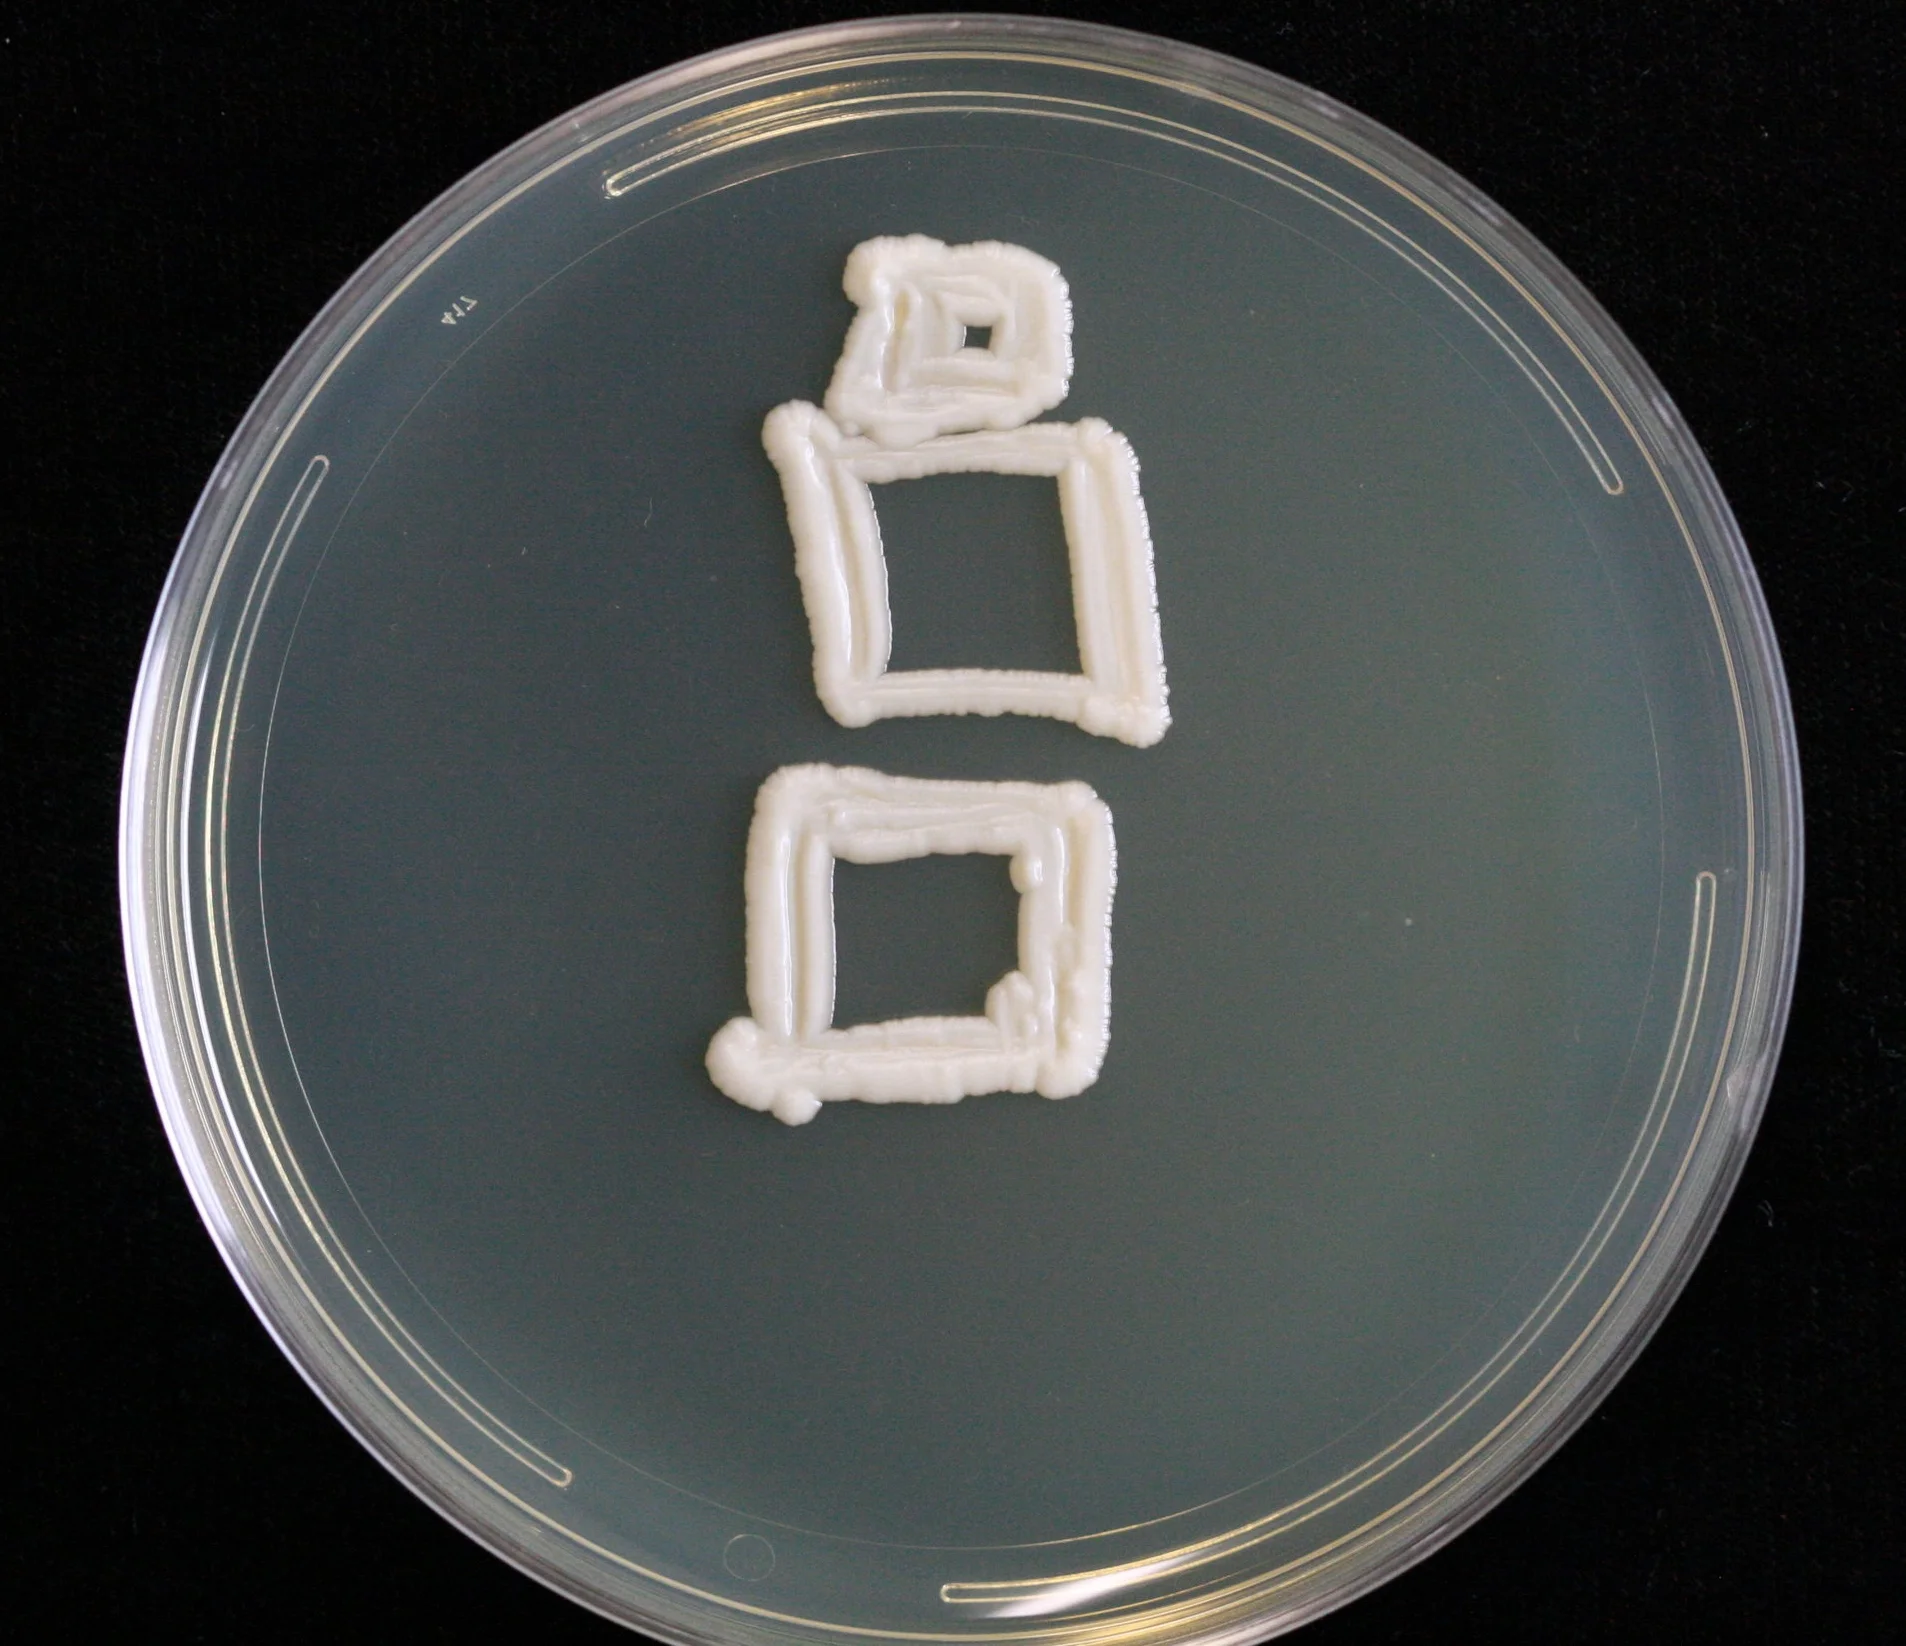
9.1.2016_6.JPG
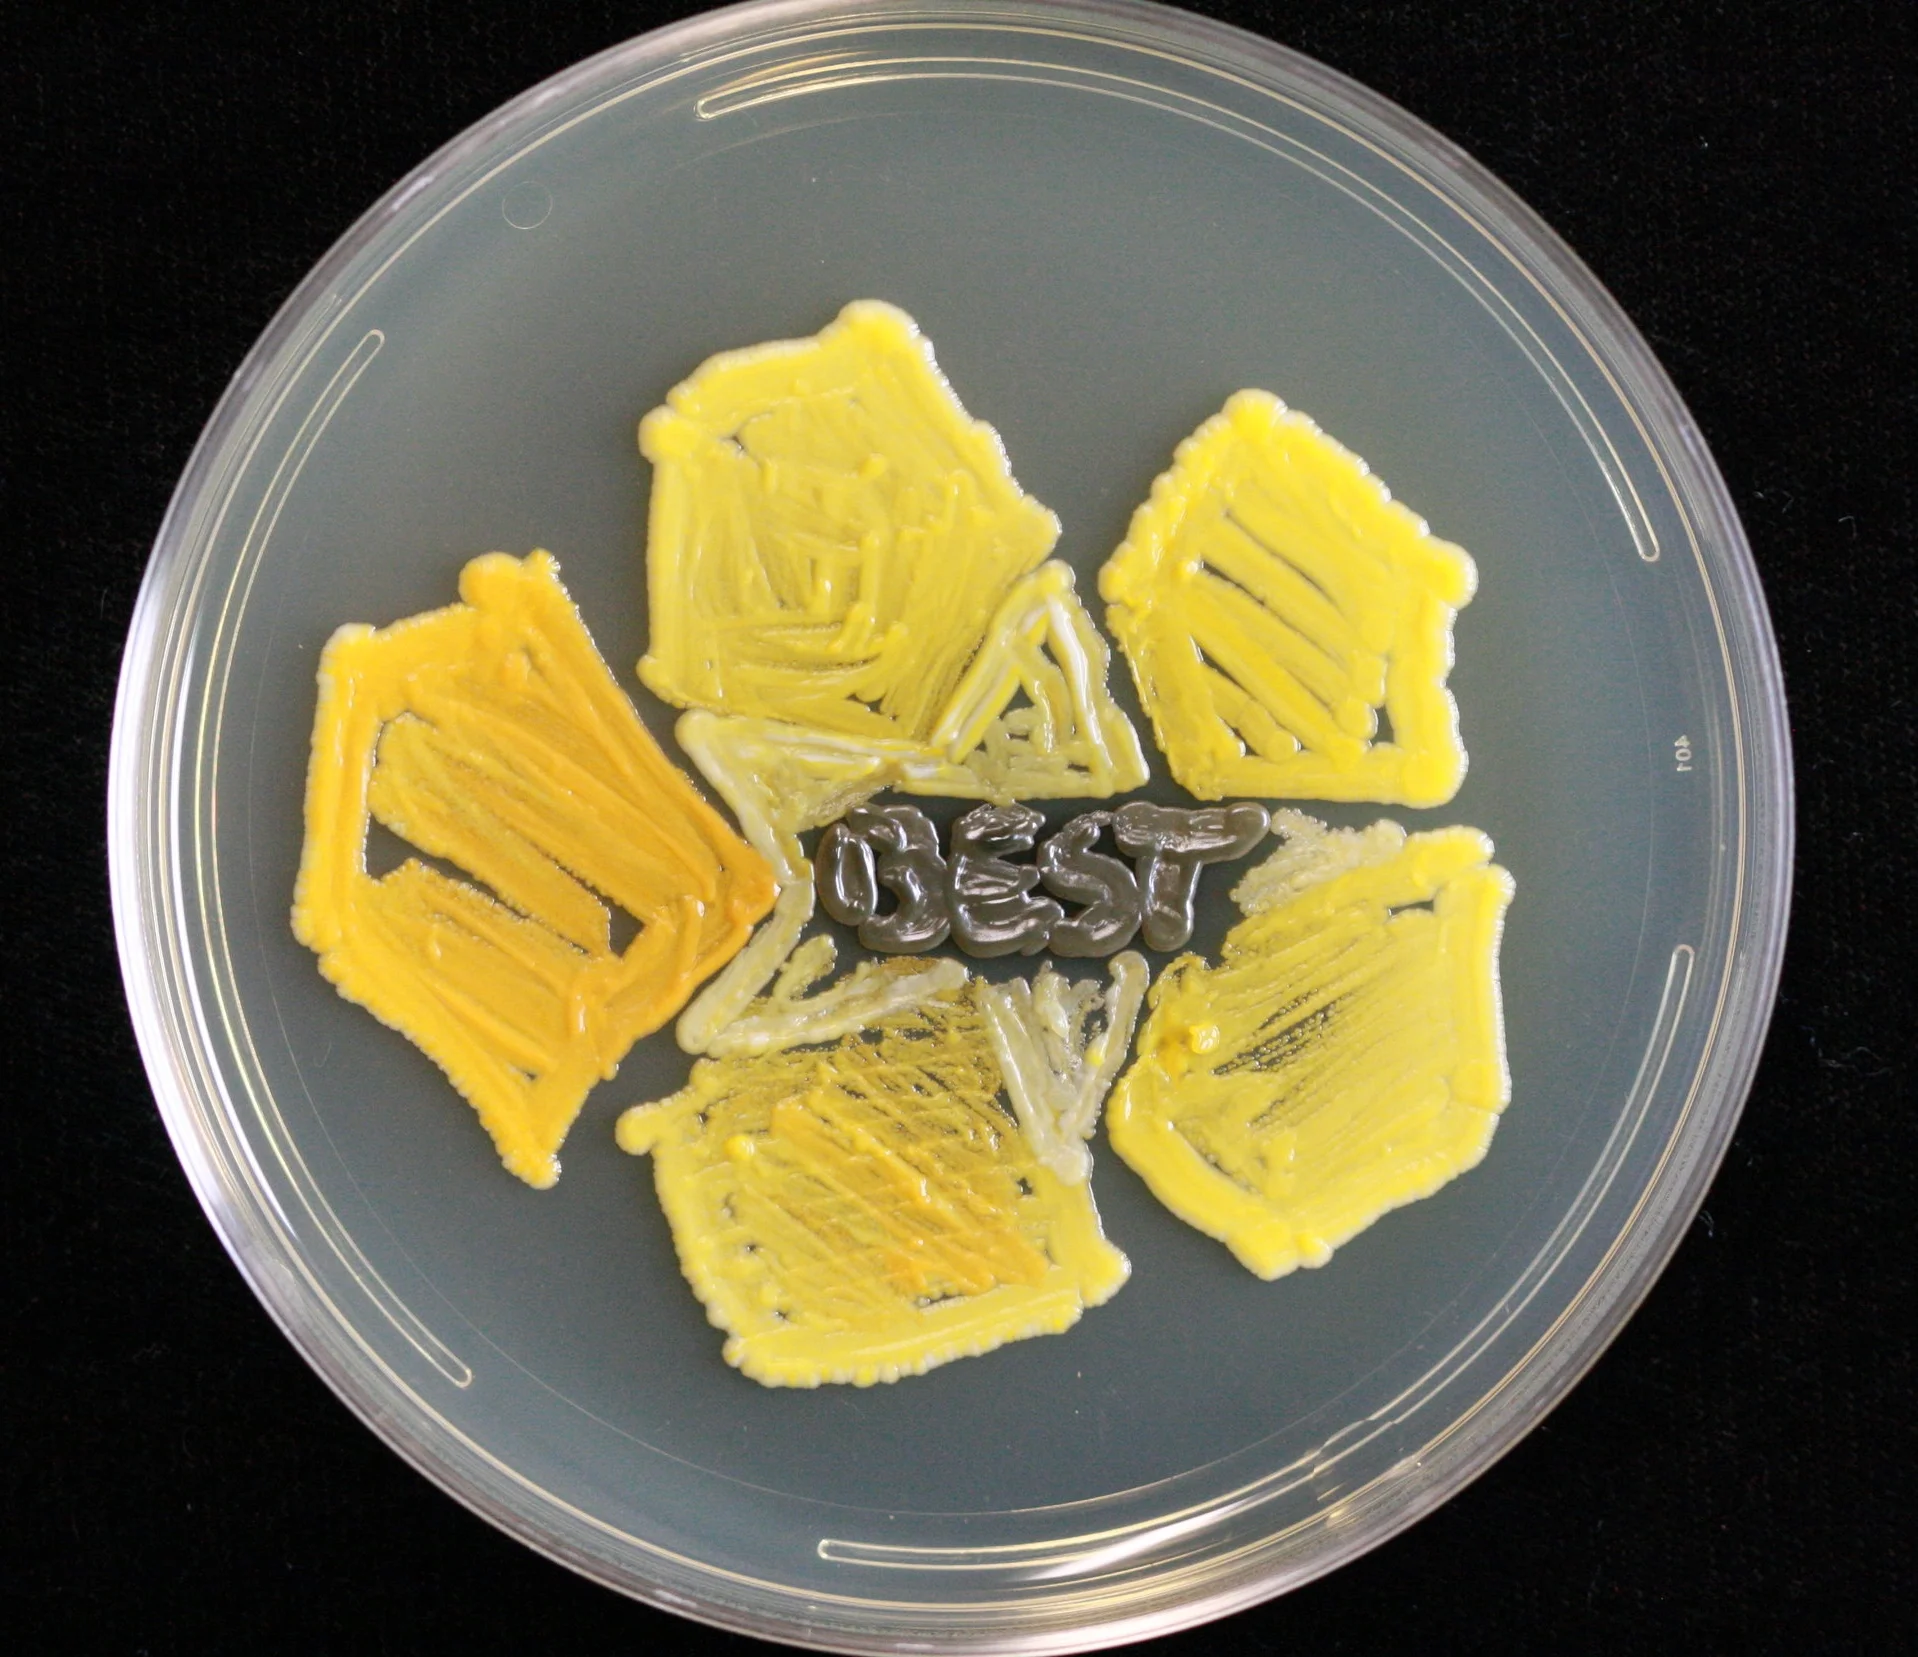
9.1.2016_7.JPG
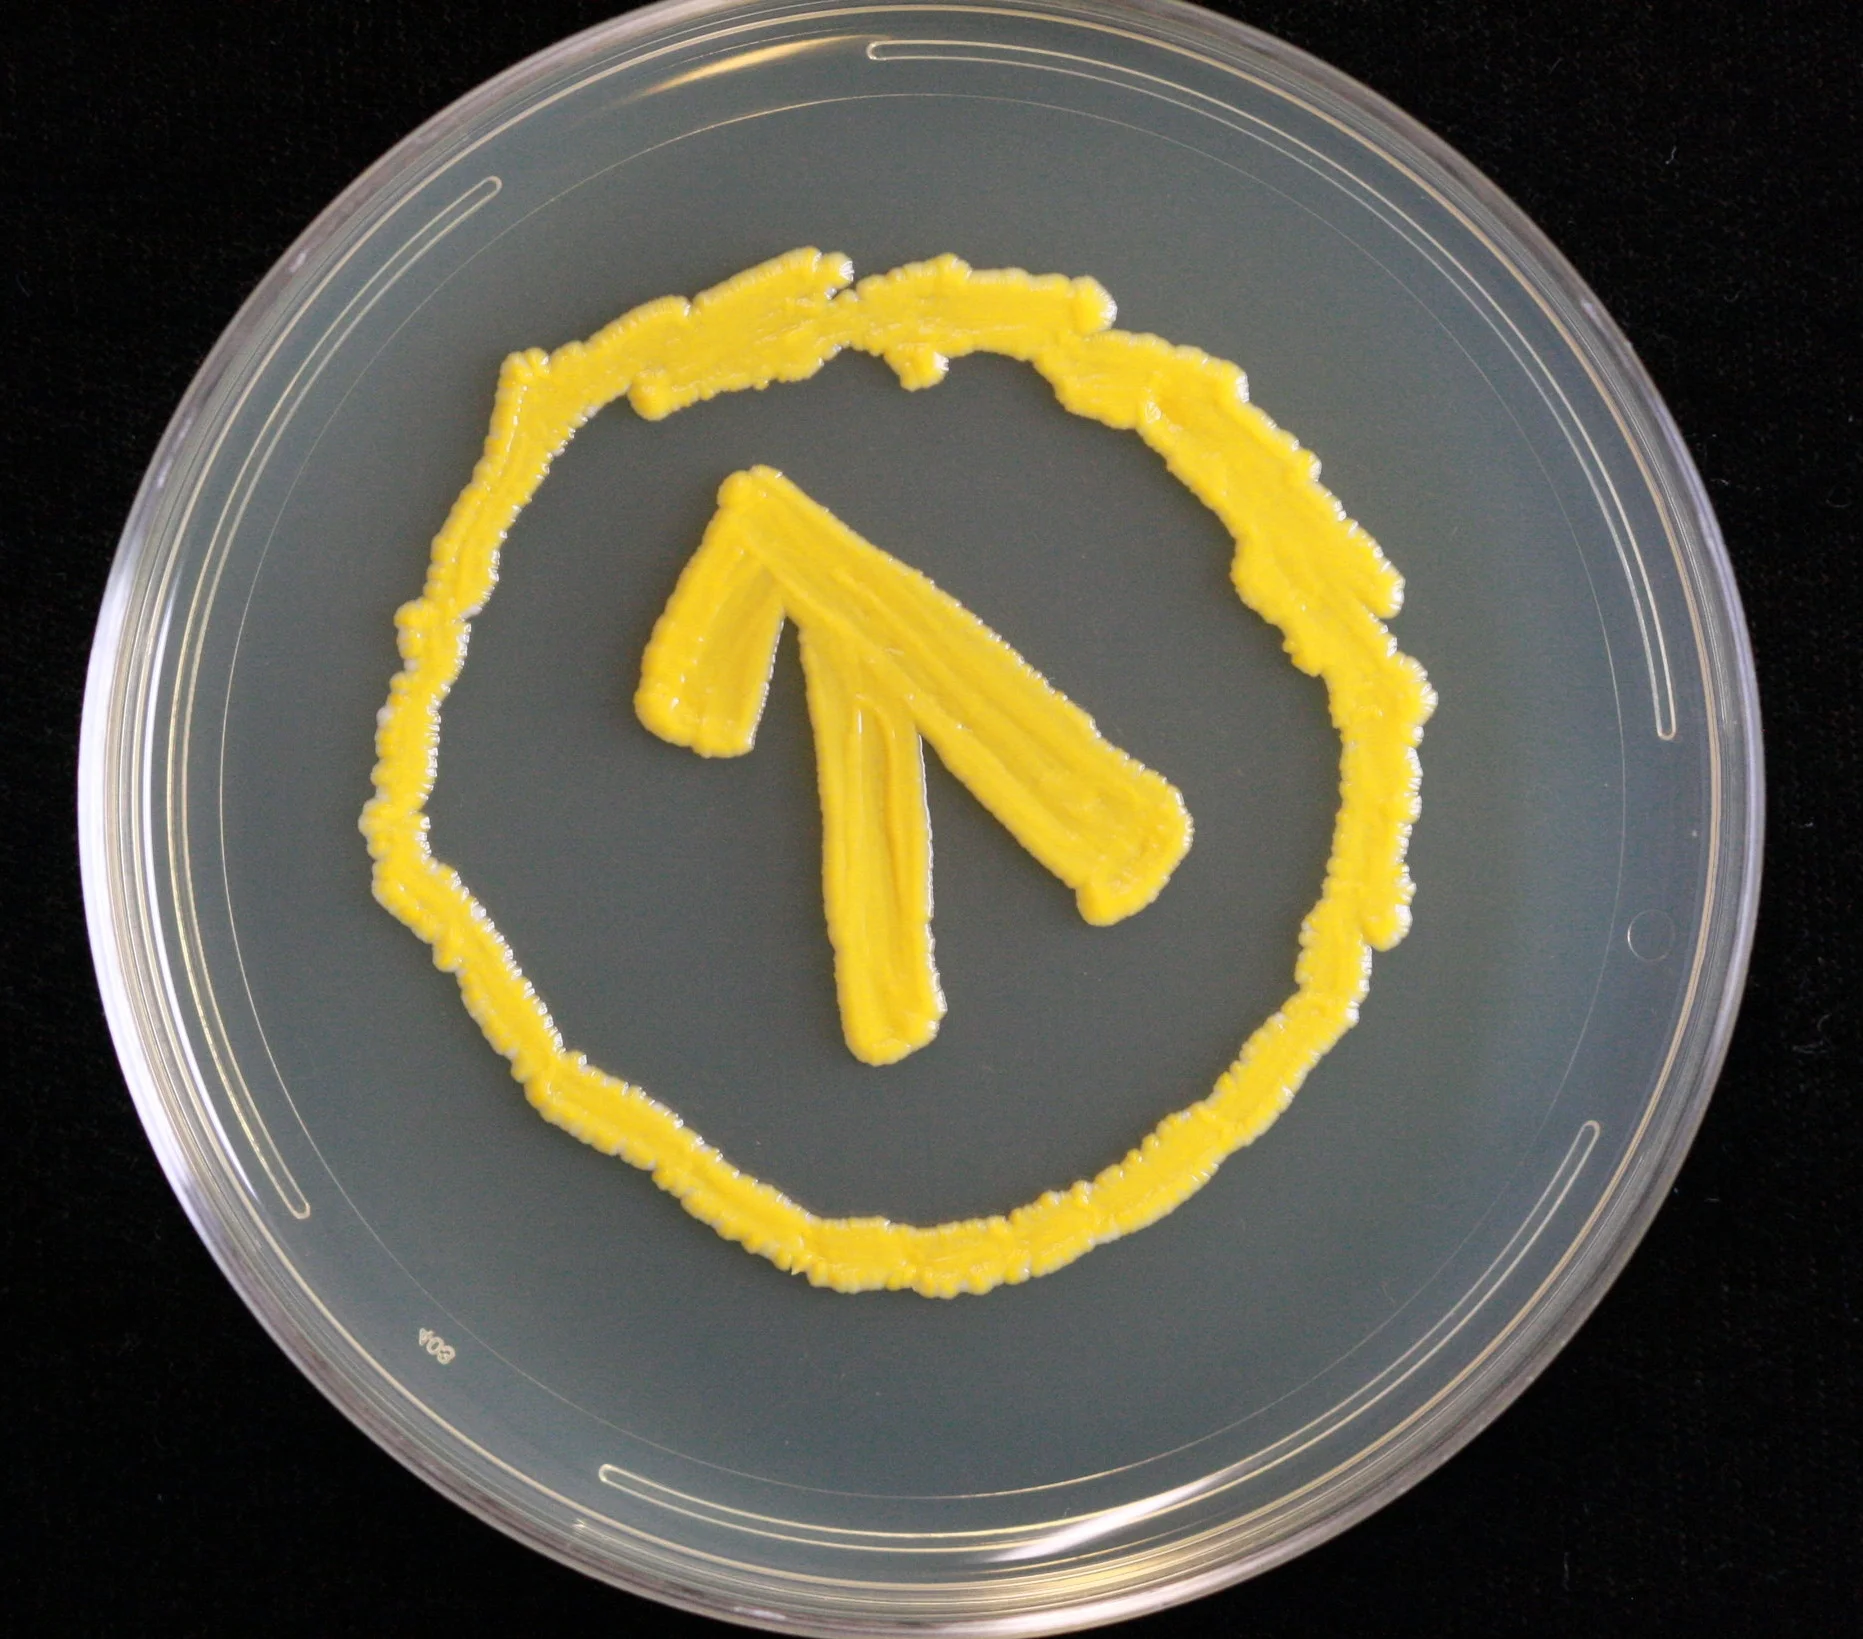
9.1.2016_8.JPG
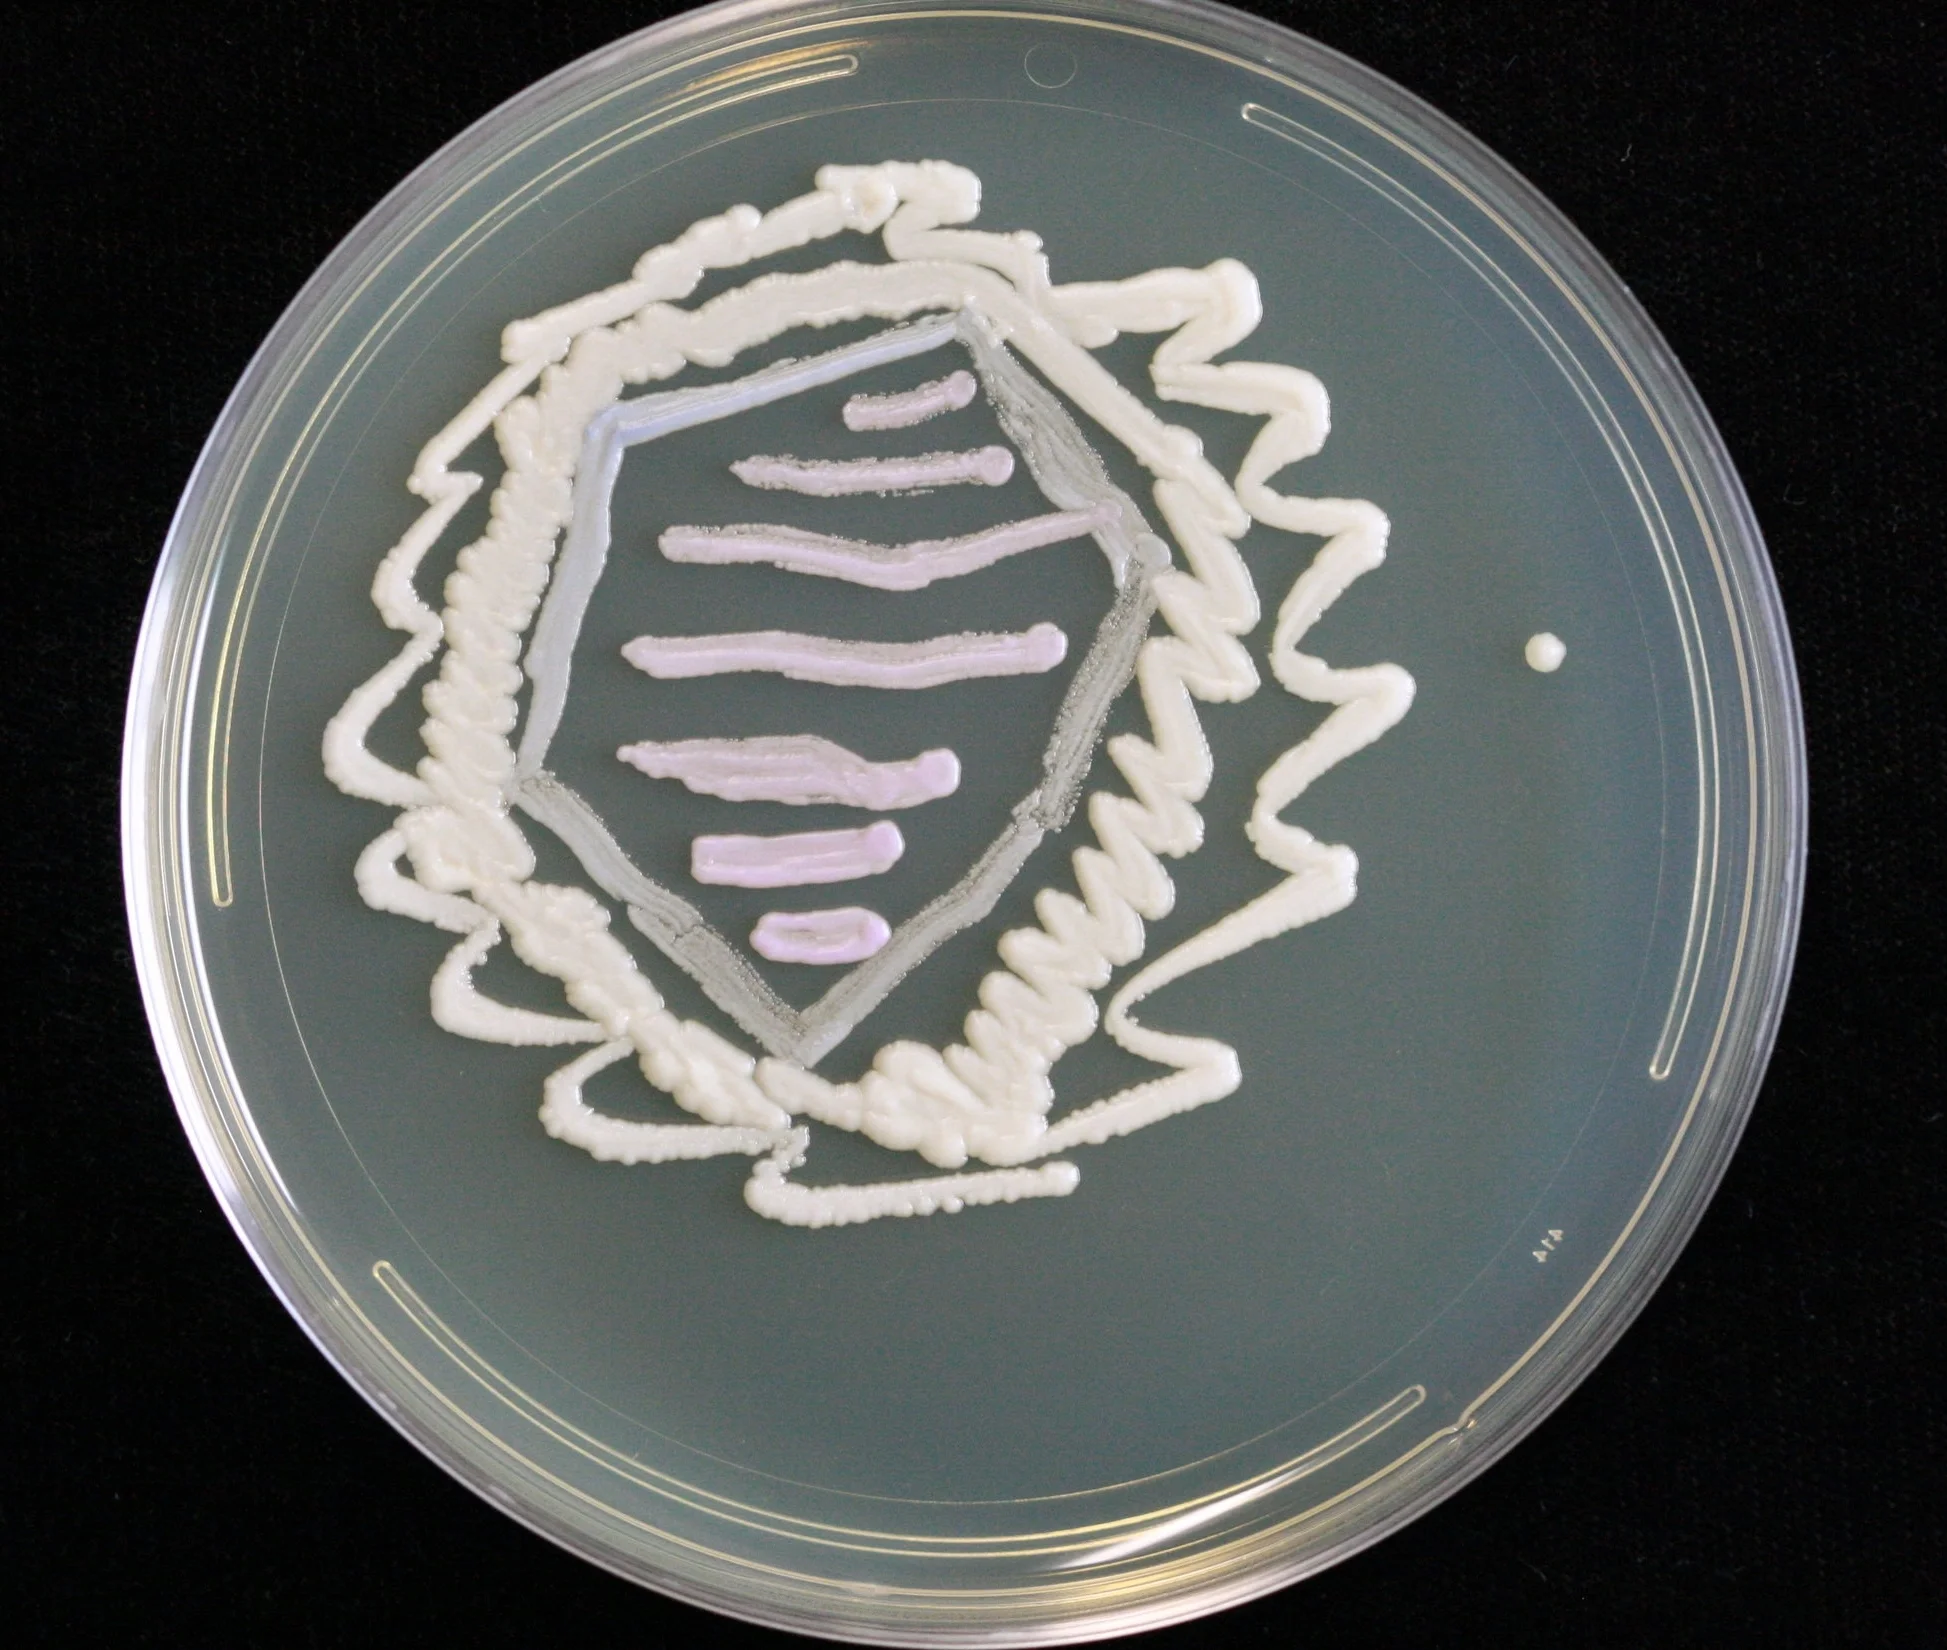
9.1.2016_9.JPG
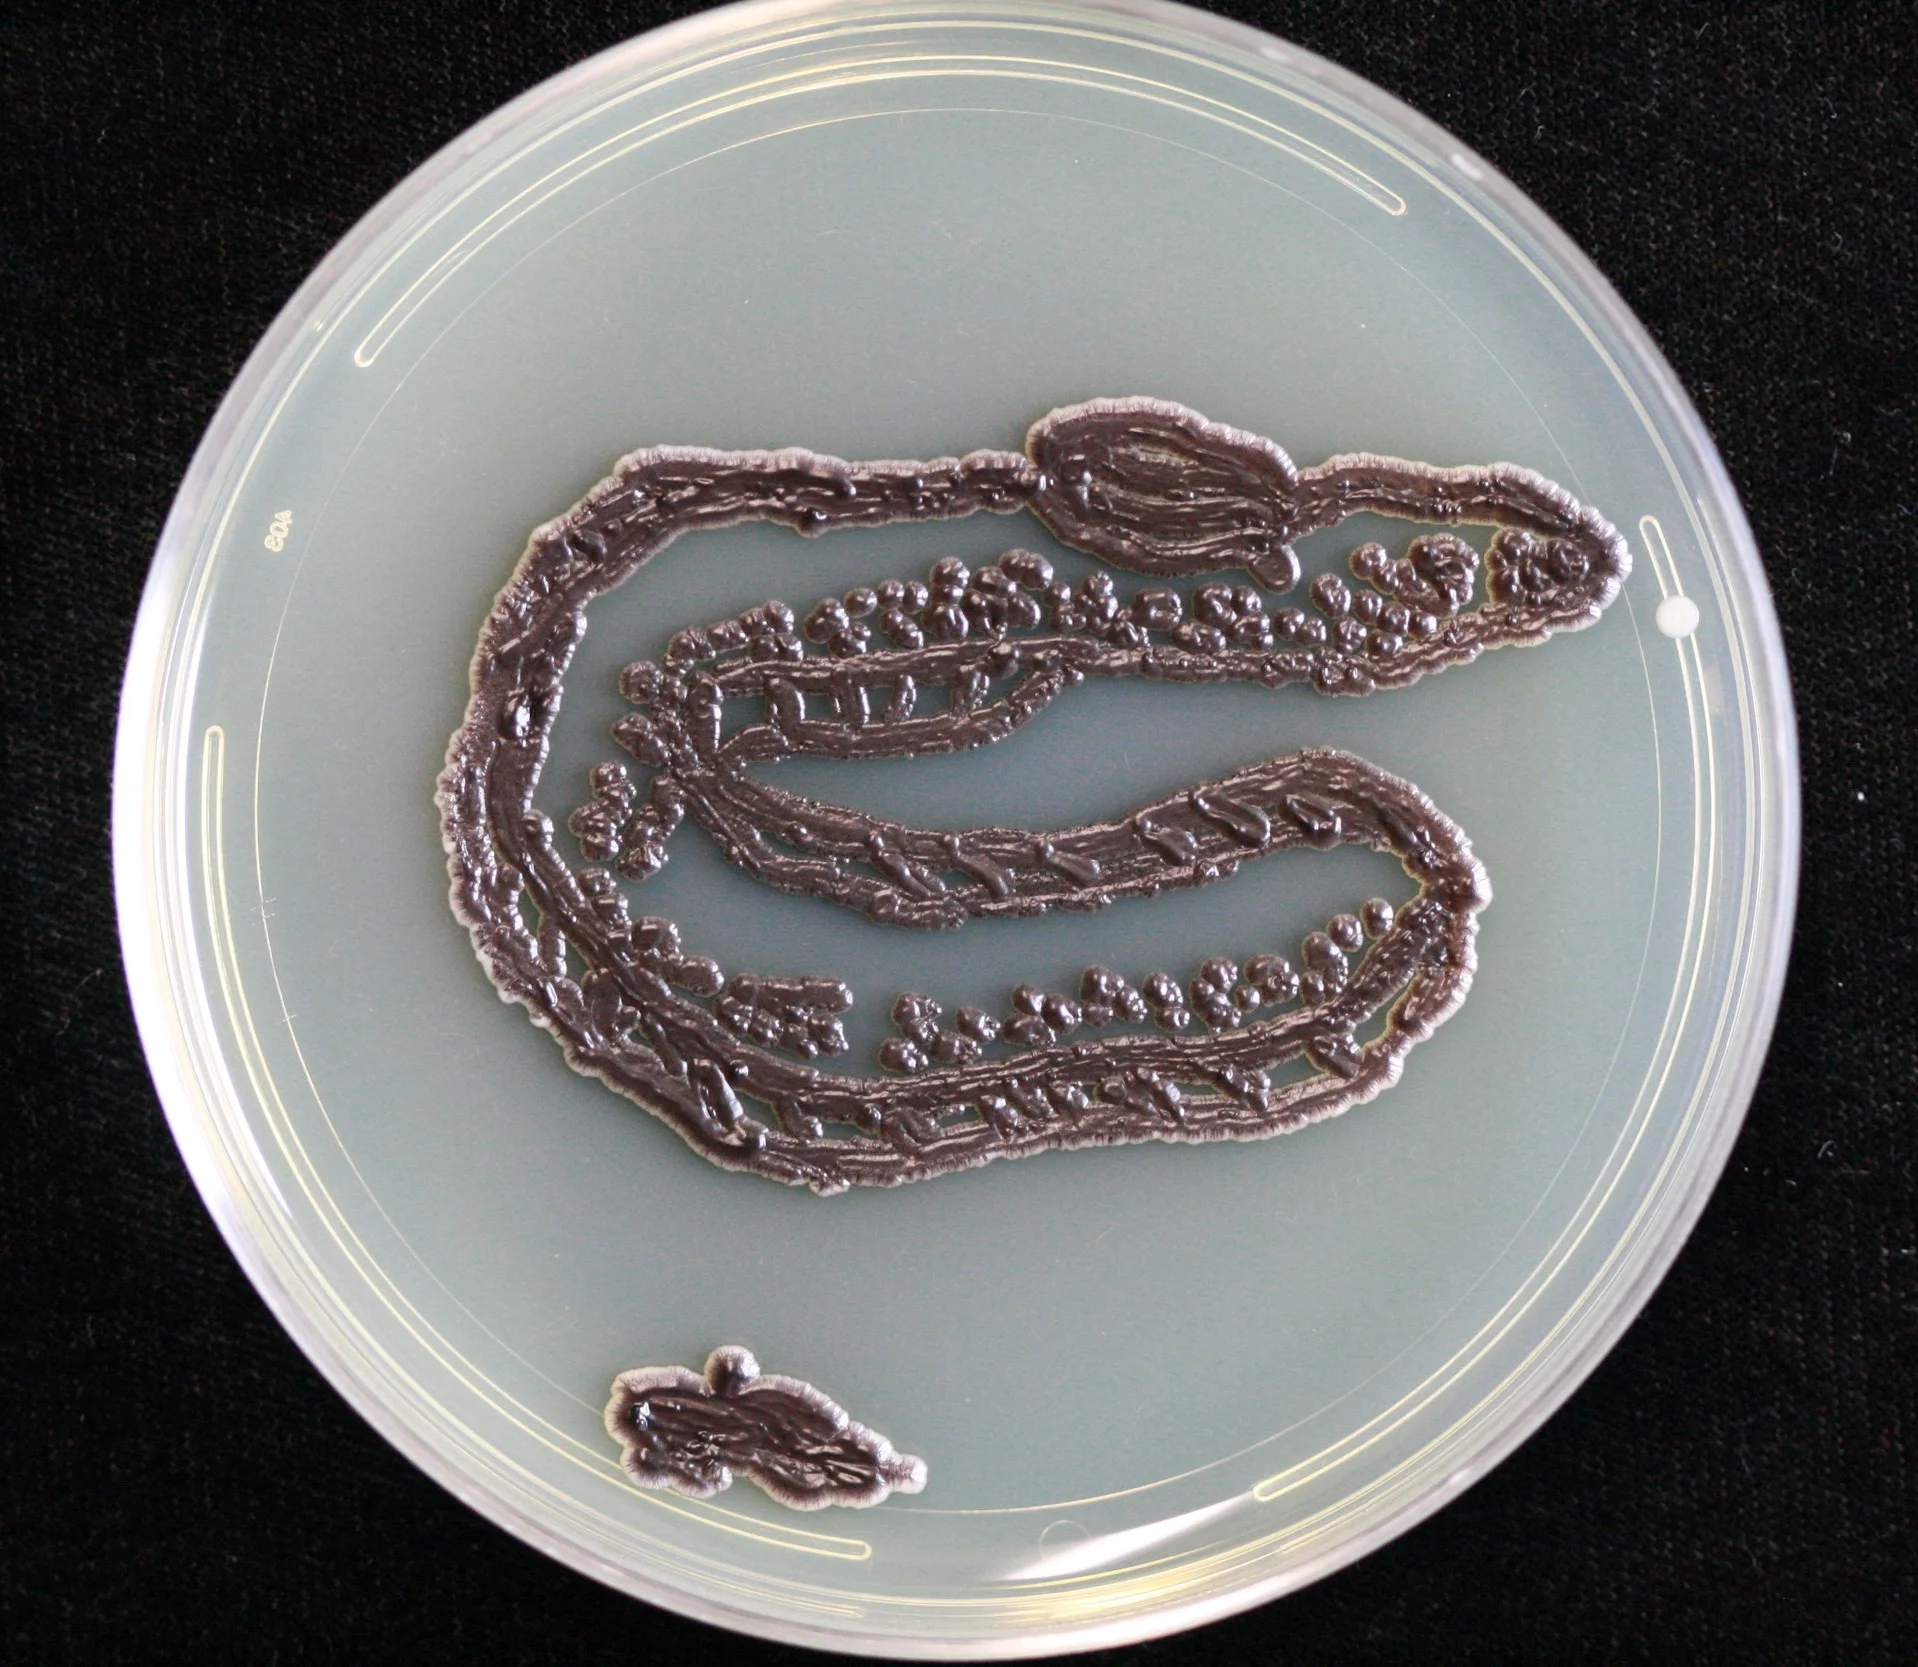
9.1.2016_11.JPG
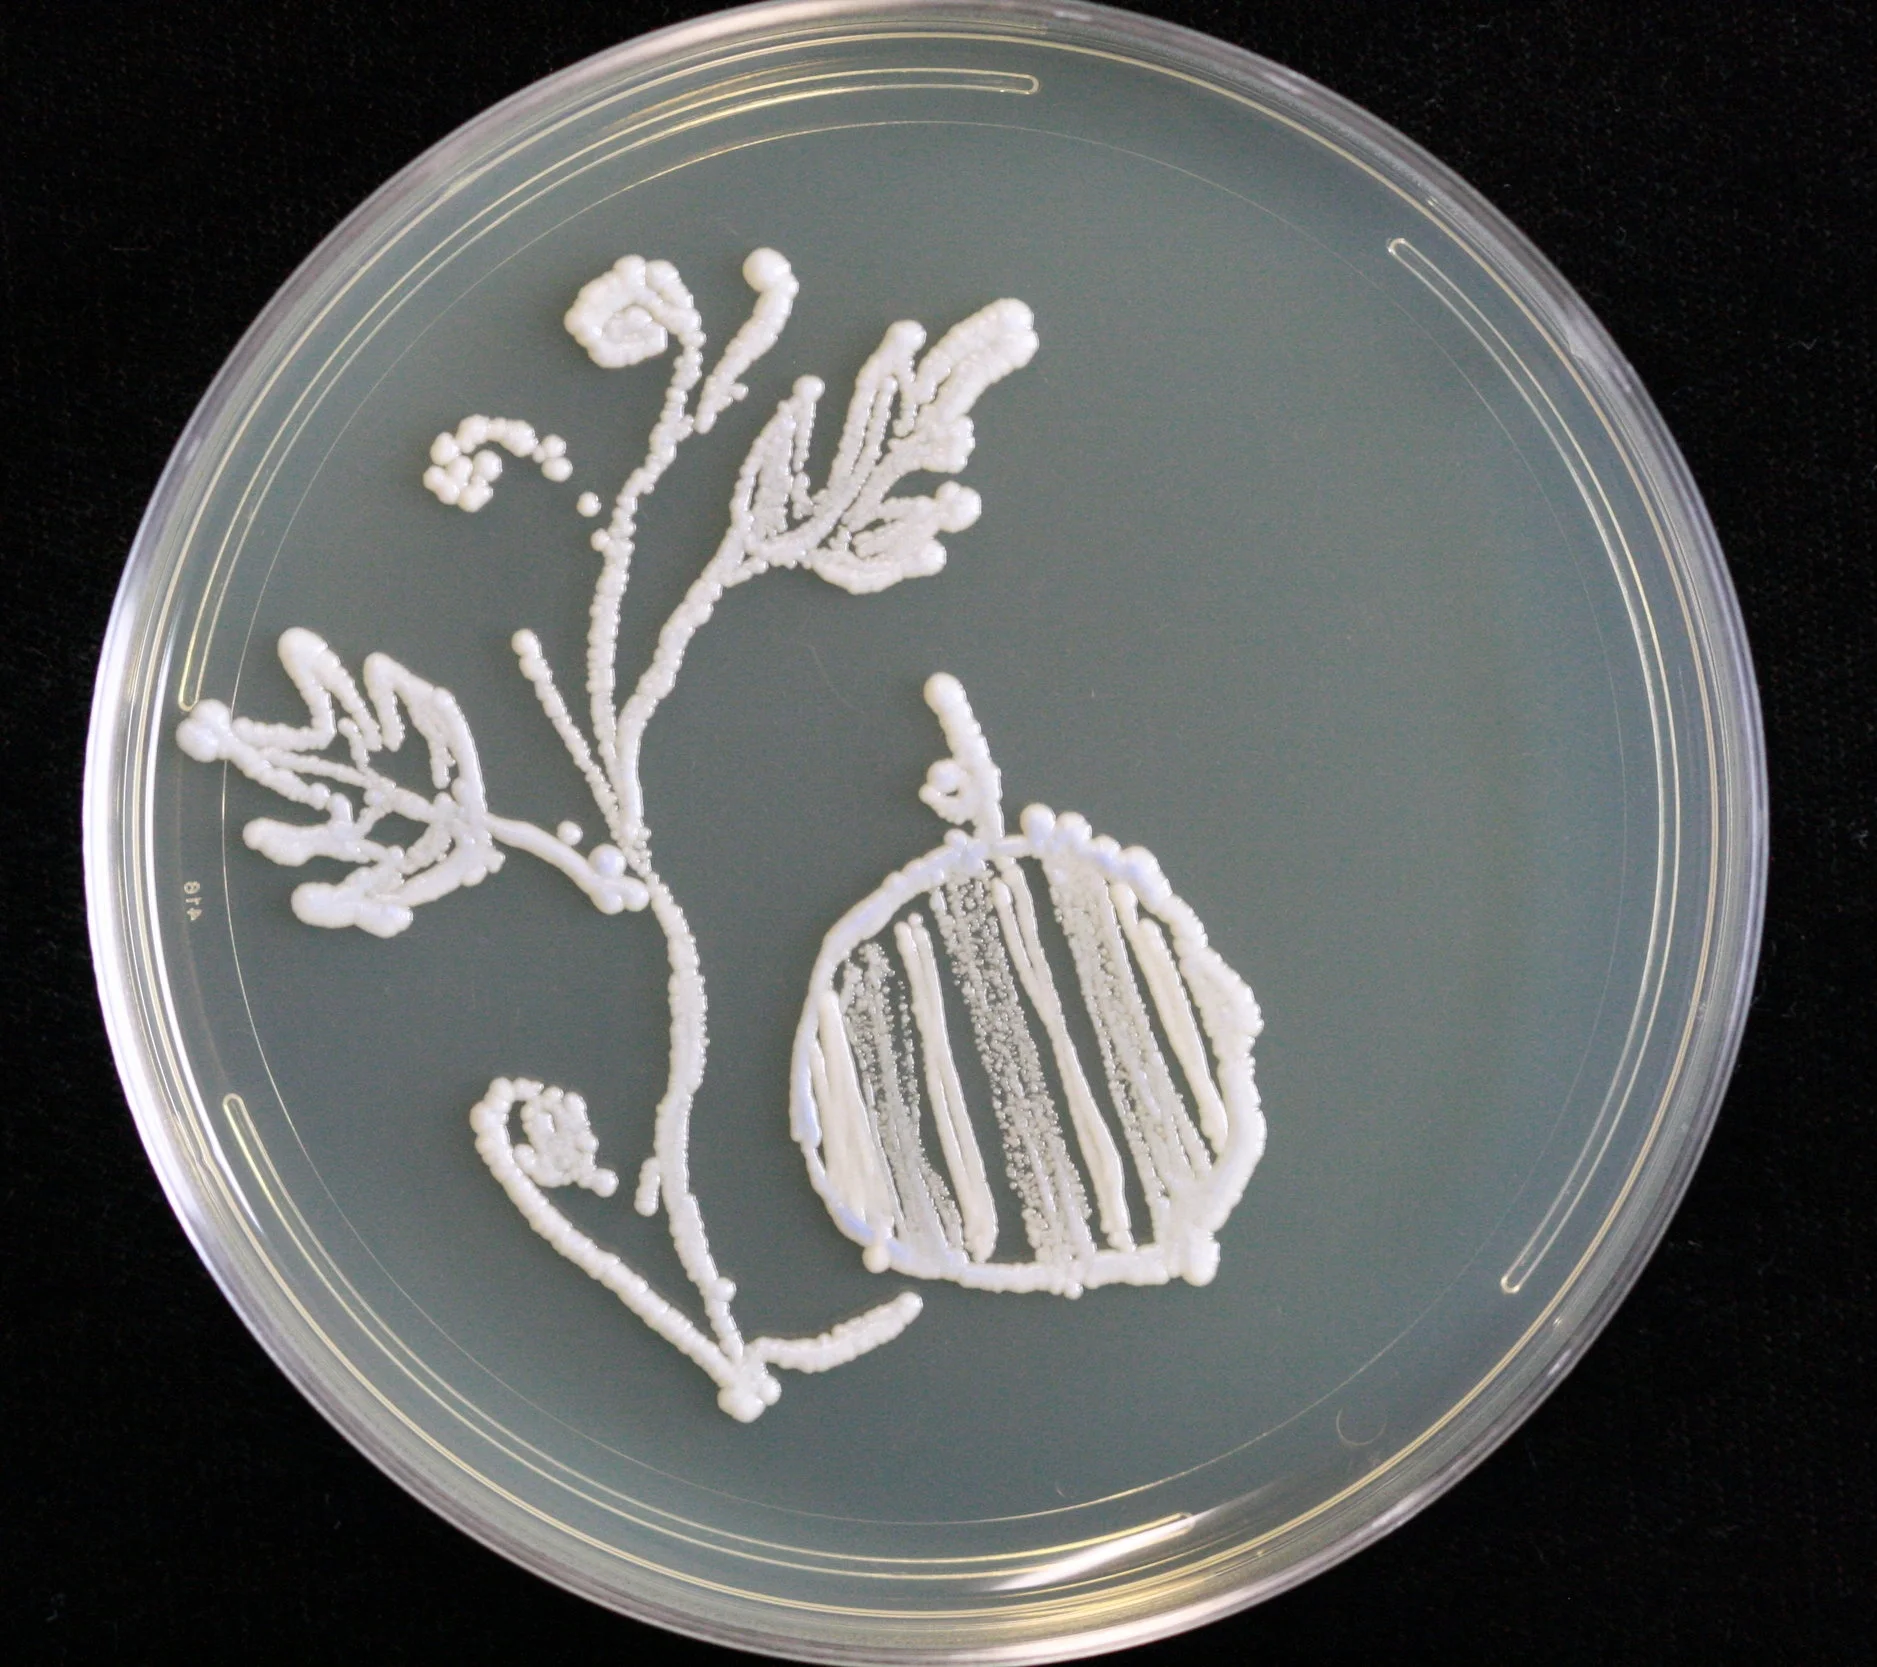
9.1.2016_12.JPG
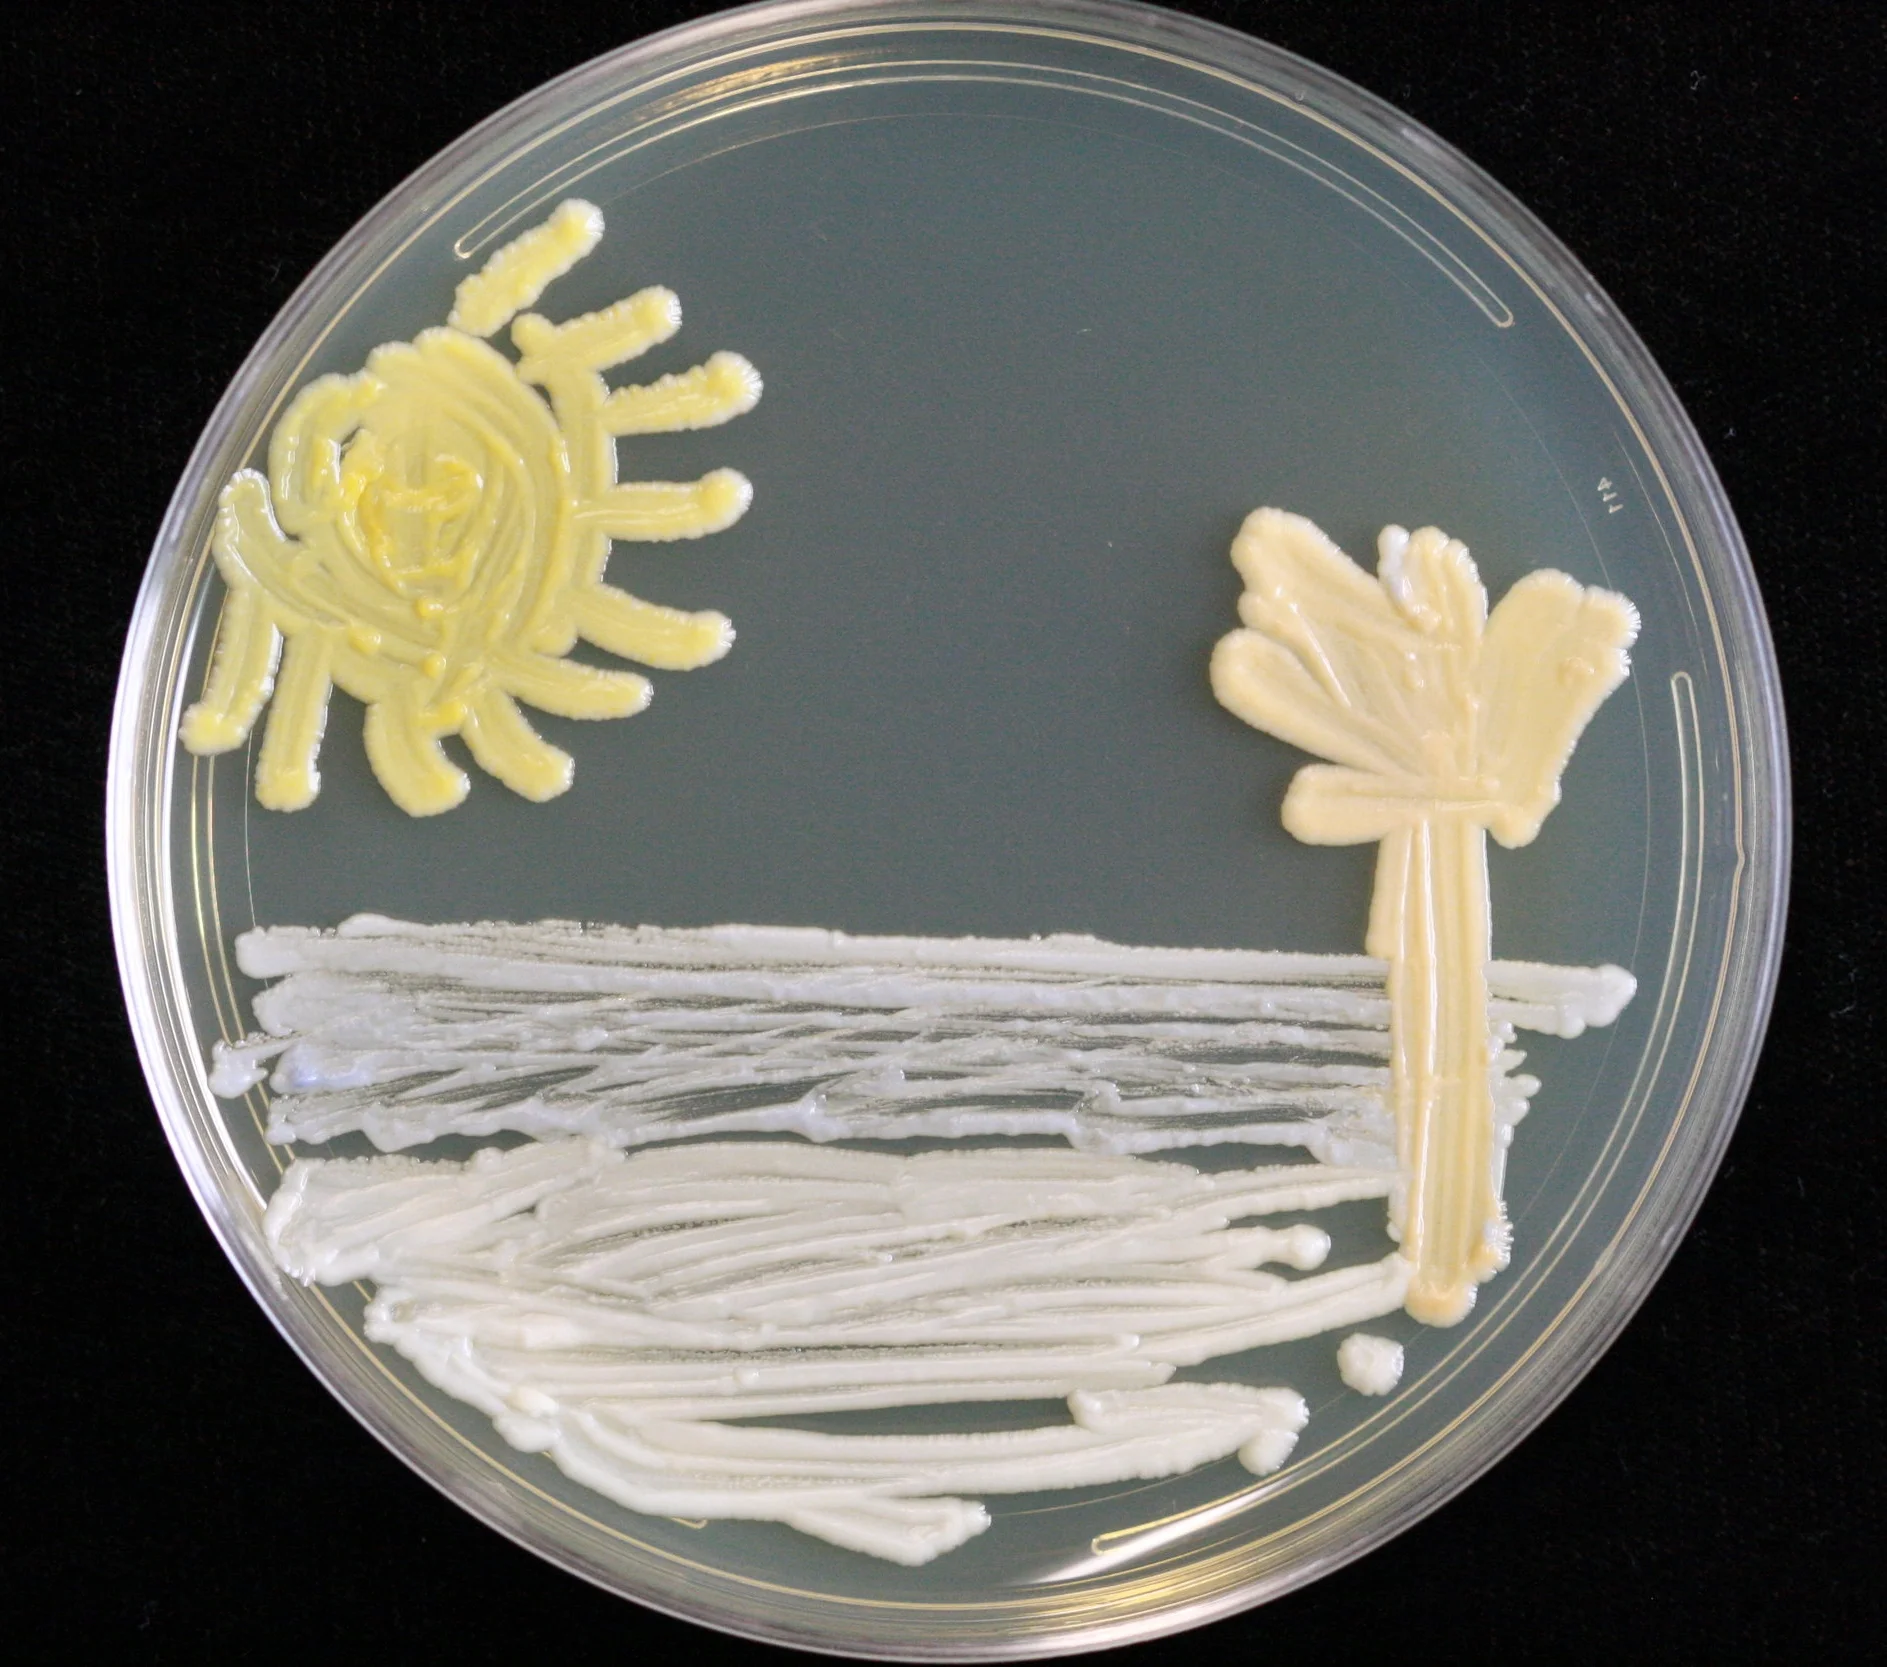
9.1.2016_13.JPG
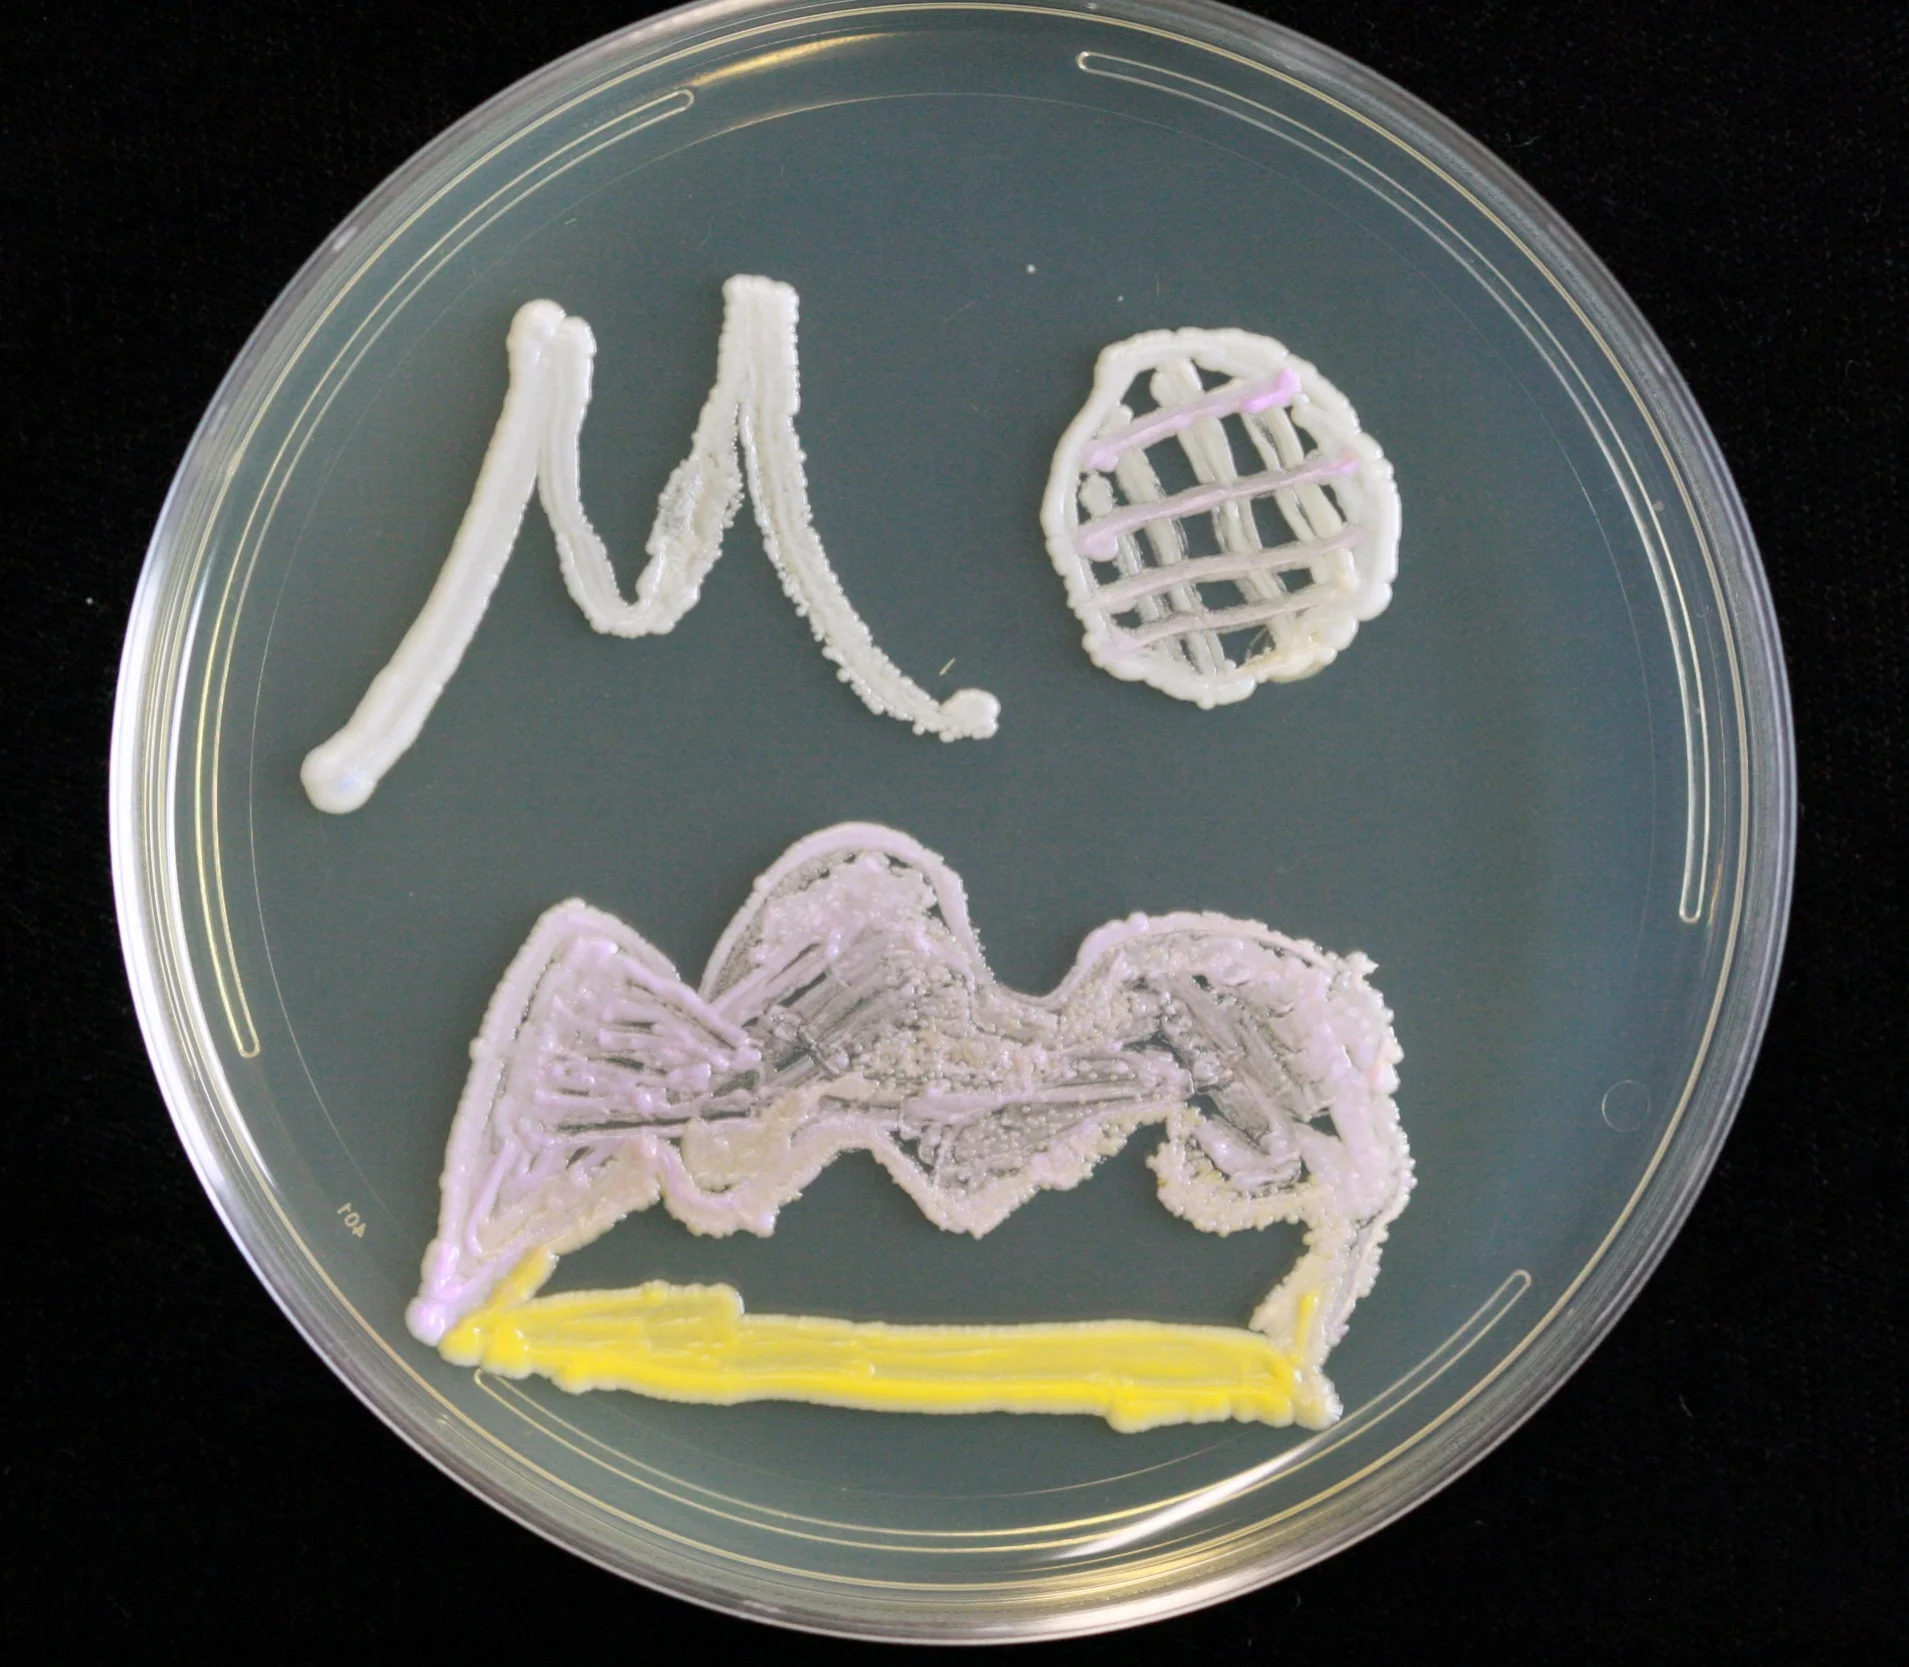
9.1.2016_19.JPG
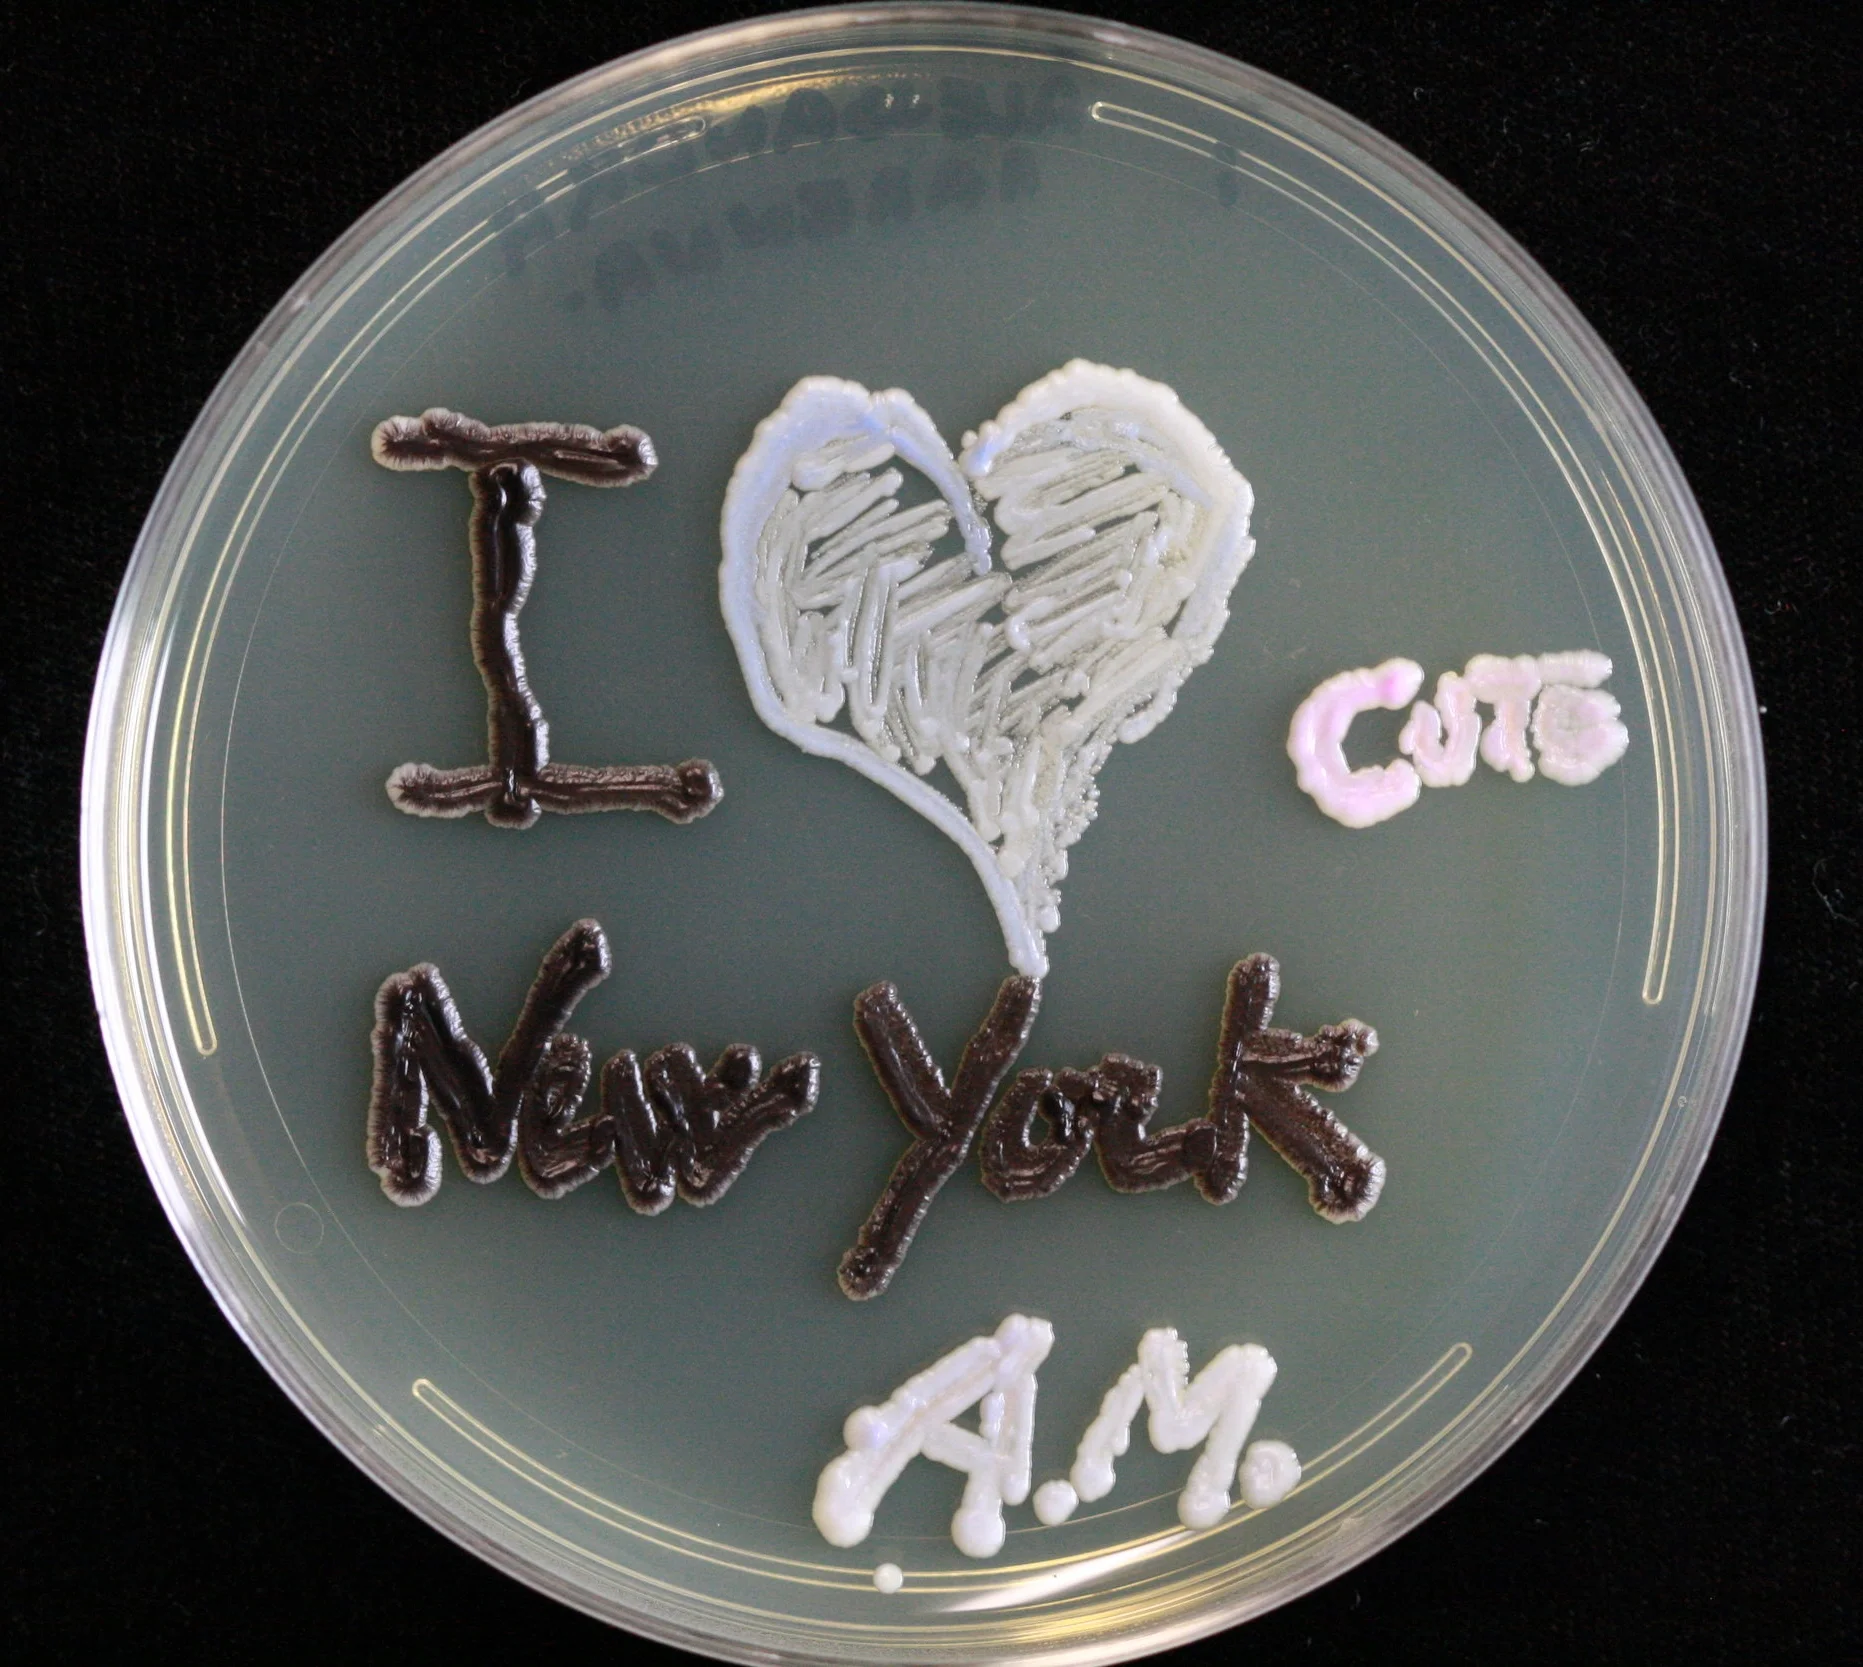
AM_9.1.2016.JPG
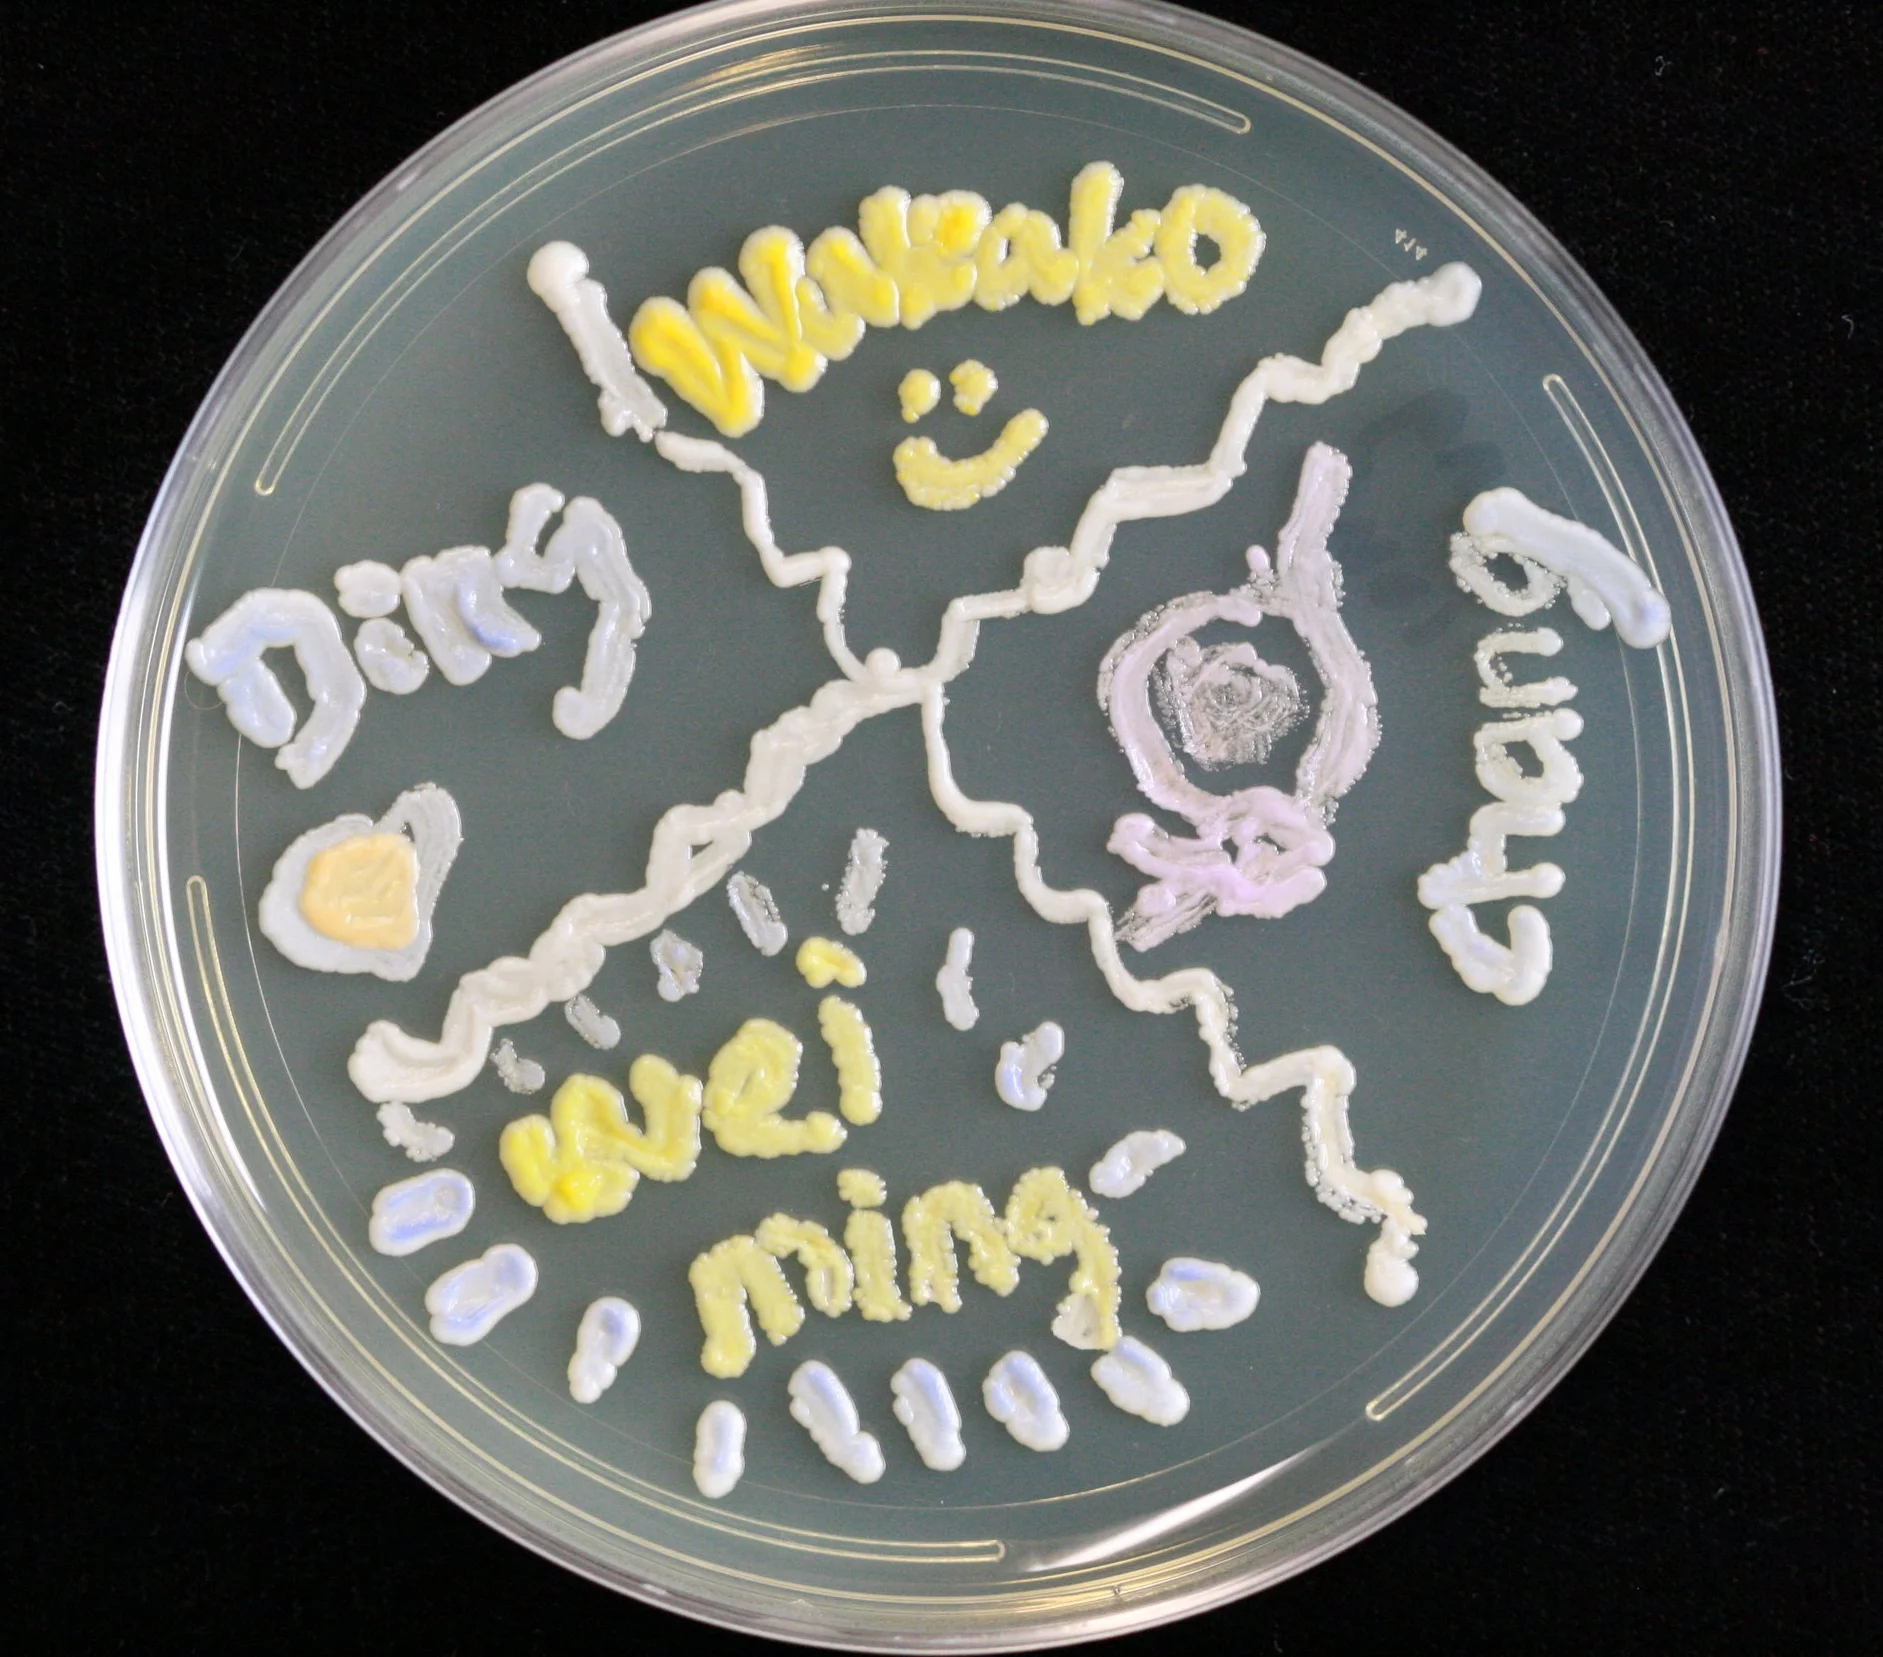
DingLouv_9.1.2016.JPG

1
2
3
4
5
6
7
8
9
10
11
12
13
14
15
16
17
18
19
20
21
22
23
24